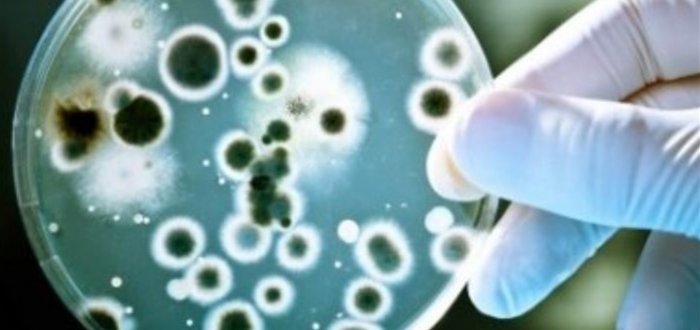

- Фільтр по
- Категорії
- Теги
- Автори
- Показати всі
- Усі
- Аналітика
- Блоги
- Важливі новини
- Вибір редакції
- Ексклюзив
- Інтерв'ю
- Кіно афіша
- Не для Топ 5
- Новини
- Регіональні новини
- Слайди
- Театри і концерти
- Телеграм
- Усі
- "Адмірал Ессен"
- "Греммі"
- "Душа"
- "Кракен"
- "Летючий Кремль"
- "недружні" країни
- "Палтус"
- "Свобода Росії"
- "Серце до серця"
- "справа_рюкзаків"
- "ступа" Баби Яги
- "шехерезада"
- "Щука-Б"
- «Lutsk Food Fest»
- «Вільна Росія»
- «ДЮСШ_№2
- «Укрзалізниця» обшук
- \
- #я_з_патіо
- 1 квітня
- 1 кітня
- 1+1
- 10 листопада
- 10 років
- 11 листопада
- 12 канал
- 12листопада
- 13_школа
- 14
- 14 бригада
- 14 жовтня
- 14_бригада
- 14_листопада
- 14)бригада
- 140 метрова яхта путіна
- 14ОМБ
- 1С
- 2 тур
- 200 балів
- 2018
- 2020
- 23_лютого
- 25_садочок
- 260
- 27_школа
- 3грн
- 41_спиртзавод
- 5 років
- 51_бригада
- 52_бригада
- 58 автомобілів
- 64-та мотострілецька бригада
- 8 березня
- 8 травня
- 9 травня
- 9_травня
- AC/DC
- Art&Гарт
- AstraZeneca
- BMW
- CCleaner
- Coca-Cola
- COVID-сертифікат
- cбу
- daKooka
- Dustards
- F-15
- Family weekend
- Fashion Week
- Forbes
- G20
- GothiaCup
- iPhone X
- Jerry Heil
- KFC
- Kongsberg
- Lampa.doc
- Linkin Park
- Lutsk night cinema
- Lutsk_Food_Fest
- Lutsk_Night_Cinema
- McDonald’s
- Meridian_Lutsk
- MI-6
- Minuteman III
- MONATIK
- Motanka
- Numb
- ONUKA
- Oracle challenger Seies Houston
- OSSA
- Parasol
- PbV-501
- Pixar
- QR-код
- Tattingkate
- Tesla
- Tik_Tok
- Tomorrowland
- uCRAZYans
- USAI
- Vodafone
- YouTube
- А_0959
- АА
- абітурієнти
- аборт
- Абрамчук
- Аваков
- авангард
- аварійний дах
- аварія
- аварія підгайці
- Аварія_Луцьк
- Аверс
- авіабаза
- авіакатастрофа
- Авіаклуб Луцьк
- авіанавчання
- авіаперельоти
- авіапробіг
- авіатор
- авіаудар
- авіаудари
- авіація
- авіашвидка
- австралія
- австрія
- автівка
- автівки
- авто
- авто в озері
- автобус
- автобуси
- автозлодій
- автокефалія
- автокрадії
- автокрадій
- автомайстерня
- автоматичну зброю
- автомобілі
- автомобіль
- автономія
- автопробіг
- авторинок
- автостанція
- автохам
- автошколи
- агенство кіберзаходу
- агент
- агент_кремля
- агітація
- агкоголь
- аграрії
- аграрна партія
- Аграрна партія України
- аграрна_партія
- агресія Росії
- агропромисловість
- Ада Роговцева
- адаптивний_карантин
- адвока-хабарник
- адвокат
- адміеністрація Байдена
- Адреналін
- адреналін сіті
- адреналінсіті
- адріатика
- аеродром
- аеропорт
- аес
- Азаров
- азартні_ігри
- Азербайджан
- Азія
- азотна кислота
- азс
- Айдар
- айсберг
- айхо
- акафіст
- акваторія Чорного моря
- Акопов
- Аксеновська
- активи
- активісти
- активна_нація
- актор
- акторка
- акциз
- акція
- акція протесту
- акціявійськових
- акціяздачі крові
- алабай
- Албанія
- Алевтина Приходько
- алеї
- Александров
- алергія
- алея
- алея писанок
- Алєня
- аліменти
- алкоголб
- алкоголізм
- алкоголь
- алкогольне_отруєння
- алкоцех
- алла пугачова
- алла рогозіна
- алмази
- Алроса
- Альберто Фернандес
- альпінізм
- ам
- аматори
- аматорська_ліга
- амбулаторії
- амбулаторія
- американець
- Американський режисер Кері Фукунага
- Амесо
- амністія
- аморальні фото
- амстердам
- амфв
- амфетамін
- аналітика
- аналітики
- Анатолій франчук
- анатолій_галамазда
- анафема
- англійська
- Андреєв
- андрій мягков
- Андрій Омельчук
- Андрій Петрушко
- Андрій Пиріг
- Андрій_Козюра
- андрія
- андрусяк
- Андрущенко
- анексія
- ані лорак
- анімація
- аномальна_спека
- ансамбль
- Антарктида
- антидот
- антикорупційний суд
- антитерористичні навчання
- антитіла
- антихрист
- антон кривицький
- Анцух
- аолинь
- апаратура
- апеляційний суд
- Апостол
- аптека
- арабська
- Арестович
- арешт
- арешт рахунків
- арештДубневича
- арештовані активи
- аріна самчук
- Армен Саркісян
- армія
- Армія РФ
- армреслінг
- арсенал
- Арт_кафедра
- Артеменко
- Артур Поляков
- археологи
- архівація
- архітектор
- АССА
- астероїд
- АТБ
- атлантида
- атлети
- атлетик
- атлетік
- АТО
- атовець
- атовці
- атомний човен
- атошники
- Атременко
- аудиторія
- аукціон
- Афганістан
- аферист
- Афіни
- Африка
- африканська чума
- африканська_чума
- афробандерівець
- ахметов
- Аштонян
- Аякс
- Б-52
- баба
- баба соня
- бабин яр
- Бабій
- Бабіляс
- Бабіна
- бабкін
- бабуся
- баварія
- Багаєв
- багатодітна родина
- багатоповерхівка
- Багінська
- Бадрак
- база відпочинку
- базарники
- байден
- байдовський
- байкер
- байкери
- байовики
- Байчук
- бакалавр
- Баку
- бал
- бала
- баланюк
- балі
- балістична ракета
- балістичні цілі
- Балкани
- балканські країни
- балкон
- балони
- Бальчун
- бандера
- Бандерштат
- бандерштат. цифри
- бандештат
- бандура
- Банзерук
- банк
- банкіри
- банкноти
- банкова
- Баран
- барбі
- Барва
- барви творчості
- Барикади
- Барселона
- баскетбол
- Батьківщина
- Батьківщина-мати
- батько
- Башкаленко
- баян
- бджоли
- Беата Куркуль
- Безва
- Безвербний
- безвідкатні протитанкові гармати
- безвіз
- безвісти_зниклі
- безкоштовна
- безкоштовний_вхід
- безкоштовний_проїзд
- безмеж
- безпека
- безпечне місто
- безпечнемісто
- безпілотник
- безпілотник Switchblade
- безпілотники
- безробітні
- безробіття
- безхатьки
- Бекешкіна
- Беломоіна
- Беломоїна
- бельгія
- бен ходжес
- бензин
- беннер
- Беннінгтон
- Бердичів
- Бердянськ
- Береза
- Березак
- Березан
- березень
- березовий сік народна медицина
- Берестечко
- береськ
- Берлін
- берлусконі
- Берлын
- берченко
- бесіда
- бетонний_завод
- бєдронка
- Бєлгородська область
- Биківня
- бібліотека
- бібліотеки
- біг
- бідні країни
- біженці
- біженці у Польщі
- бізнес
- бізнес-клімат
- бізнес-форум
- бізнес-школа
- бійка
- бійці
- бійці ато
- Бікфалві
- біле озеро
- Білий дім
- білин
- білорус
- білоруси
- білорусія
- Білорусь
- Бім
- бім-бом
- біовулики
- біометричний паспорт
- біометричний_паспорт
- біометричні_паспорти
- біометрія
- Бірюліна
- Бірючий
- блаблакар
- благовізщення
- Благодатне
- Благодатний вогонь
- благодійіність
- благодійна виставка
- благодійність
- благодійсність
- благоустрій
- блакитне паливо
- близнюки
- близький схід
- блискавка
- бліндаж
- блінкен
- блог
- блогер
- блогер-мільйонник
- блогери
- блоговіщення
- блокада
- блокування
- бляхи
- бмв
- БМП
- Богдан
- Богдан. суд
- Богдана_Хмельницького
- боголюби
- Боголюбов
- Богомолець
- Богонос
- Богословська
- богослужіння
- богуш
- боєприпаси
- боєць
- боженка
- Божидарник
- Божко
- бої
- бойовики
- бойові кораблі
- бокс
- боксер
- боксери
- болгарія
- болоховець
- бомба
- бомбардування
- Бондар
- Бондарук
- бондіана
- боратин
- борг
- борги
- Боремель
- Борис Олійник
- борисова
- Борисюк
- Боровой
- Бородянка
- боротьба
- боротьба_з_корупцією
- борохів
- борошно
- Боррель
- Борусія
- Боруссія
- борщ
- борщівник
- Босий
- ботулізм
- ботулізм. Волинь
- боулінг
- боча
- бразилія
- бразильці
- брайль_студія
- браконьєри
- браконьєрство
- брила_льоду
- Британія
- британський
- брифінг
- Брище
- бронежилети
- бронемашини
- бронза
- бруд
- Брукалюк
- брухт
- Брюссель
- Брюссель звинувачує Будапешт
- БТГр
- Буадзе
- бугров
- будинки
- будинок
- Будинок_дитини
- будинок_престарілих
- будівлі
- будівництво
- будівництво_дороги
- бужани
- Бужанка
- бужанський
- букбокси
- букети
- буковина
- Була
- булінг
- Бумбокс
- Бунда
- Бунечко
- бунзин
- бурба
- Бурбак
- буревій
- буржуйка
- бурі
- БУрнейко
- бурчин
- бурштин
- бурштин волинь
- буряки
- бус
- Бутко
- Бутусов
- Буча
- Бучак
- Бхарті
- Бэлковський
- бюджет
- Бюджет участі
- бюджети
- Бюджетний_кодекс
- бюджетні установи
- В`ячеслав Хурсенко
- в'їзд
- в'ячеслав католик
- В’єтнам
- важка зброя
- важкий_стан
- важкохворий
- ВАЗ
- вакансії
- ваканція
- Вакарчук
- вакуумна бомба
- вакцина
- вакцина. супутник
- вакцинація
- вакцинування
- Валерій_Кузьмич
- валідатор
- валідатори
- вальники
- валют
- валюта
- валюта луцьк
- валютні резерви Росії
- вандал
- вандали
- вандалізм
- вандли
- вантажівка
- Варта_порядку
- вартість
- вартість проїзду
- Варфоломій
- Варшава
- варшавський
- Василевський
- василенко
- Василь Боднар
- василь рижук
- ватажки
- Ватикан
- Ващенюк
- Ващиковський
- вбив
- вбивають мирних жителів
- вбивства
- вбивство
- вбивтство
- вбивця
- вбиральня
- вбита
- вбиті
- вв
- вдова
- ведмеді
- Велика Британія
- Велика двадцяткаАвстралія
- великдень
- Великдень та загроза провокацій
- Великий Омеляник
- великий_піст
- Великобританія
- Великоднє богослужіння
- великодні свята
- велимче
- Велимченськ
- Величко
- велодоріжка
- велопробіг
- велосипед
- велосипедист
- велосипедистка
- велосипедстка
- венедиктова
- венера
- венеція
- верба
- Вербич
- Веремійчик
- Верес
- Вересневе
- верещук
- вернадський
- вертоліт Ка-52
- верхівковий_короїд
- Верховна Рада
- Верховна Рада України
- Верховна_Рада
- Верховний_Суд
- Веселе
- весілля
- веслувальники
- веслування
- весна
- ветеран
- ветеран війн
- ветеран_ато
- ветерани
- ветсанзавод
- вечірка
- вечорниці
- вибори
- вибори 2019 президент
- вибори у франції
- вибори_ОТГ
- вибори_президента
- вибух
- вибухи
- вибухівка
- виверження
- вивіз сміття
- виграш
- вигул собак
- видавництво
- видавці
- видворення
- виділення коштів
- Видобуток нафти в Росії
- виїзд
- виїзд за кордон
- викид суміжних газів
- викладач
- викладачка
- виключення
- виконком
- викрадач
- викрадач машин
- викрадене_авто
- викрадення
- викрадення дитини
- викрадення_авто
- викриття
- вилов_риби
- вилучення
- вилучення_грошей
- вимирання
- вимкнення
- вимкнення світла
- вимкнення_світла
- винахід
- винник
- Винниченка
- виноградар
- випав
- випав з вікна
- випала з вікна
- виплата
- виплати
- випробування
- випуск
- випуск2018
- випускний
- випускники
- вирізати
- виродки
- вирок
- вирубка
- високоточні удари
- висота
- вистава
- виставка
- виставка_собак
- витік
- витік газу
- витрати
- вихідні
- вихованці
- вихователька
- виш
- вишивальниця
- вишиванка
- вишивка
- вишка
- Вишків
- виявили тіло
- віа гра
- вівця
- відбудова
- відведення військ
- відділ
- відео
- відео дня
- Відео новини
- Відео_дня
- відеодоказ
- відеозйомка
- відеокамери
- відеоролик знищення
- відеоспостереження
- відзнака
- відімкнення електроенергії
- відкликання
- відкликання_депутатів
- відключення
- відключення води
- відключення електроенергії
- відключення світла
- відключення_світла
- відкривай_україну
- відкриття
- відлига
- відлуння тижня
- відлуння_тижня
- відмова
- відмова від російського газу
- відновлення
- відновлення інфраструктури
- відновлення слуху
- відновлення фонтану
- відносини
- відомості
- Відошевіч
- відпочинок
- відпустка
- відставка
- відходи
- відьми
- віза
- візит
- візовий_режим
- Візор
- війкськомат
- війна
- війна в Україні
- військва техніка
- військкомат
- військо
- військова допомога
- військова операція
- військова служба
- військова техніка
- військова_підготовка
- військове_містечко
- військовий
- військовий _комісаріат
- військовий збір
- військовий злочин
- військовий лісгосп
- військові
- військові кораблі
- військові РФ
- військові_навчання
- військові_частина
- військово-патріотичний вишкіл
- військовослужбовець
- військовослужбовці
- вікінги
- вікіпедія
- вікно
- віктор гвоздь
- Віктор Пінчук
- Віктор Шелигін
- віктор_супрунюк
- вікторія павлік
- ВІЛ
- вілла
- вільна боротьба
- Віндзор
- вінницькі
- Вінниця
- Вінничина
- Віннічук
- віра
- вірастюк
- вірменин
- Вірменія
- вірус
- Вісла
- віськовослужбовці
- Віталій_Скоцик
- вітання
- вітер
- вітрила_пригод
- вітходи ветсанзаводу
- віце-чемпіонка
- ВК
- вкрали_авто
- Влад Ситник
- влада
- владивосток
- Власова
- влкогольна кома
- Влодарчик
- вмикнення
- вночі
- ВНУ
- внук
- вовки
- Вовченко
- вогняне шоу
- вогонь
- вода
- водії
- водій
- водій маршрутки
- водійка
- водійське_посвідчення
- водійські перава
- водійські посвідчення
- водійські права
- водійські_права
- водіння
- водія
- водний туризм білорусь
- водогін
- водоканал
- водопостачання
- водопостачання луцьк
- водосховище
- водяні завіси
- водяні_завіси
- воєнні знахідки
- Вознюк
- Возняк
- воїн
- ВОїни
- воїни ато
- воїни_АТО
- воїти
- войтенко
- войтюк
- Вокал
- волейбол
- волині
- волинська голландія
- волинська митниця
- Волинська обласна лікарня
- Волинська область
- волинська правда
- волинська_княжна
- волинська_лікарня
- Волинська_ОДА
- волинська_толока
- Волинська_трагедія
- Волинськаєпархія
- волинський ліс
- волинський обласний лабораторний центр
- волинськийзлочинець
- волинські водойми
- волинські_патріоти
- волинськівійськові
- волинськідонори
- волинськіфермери
- волинь
- Волинь ато
- ВолинЬ Луцьк
- волинь моя
- Волинь сильні вітри
- Волинь Точинський
- Волинь УПЦ КП
- Волинь_аварія
- Волинь_події_люди
- Волинь_світло
- Волинь_УПЦ_КП
- Волинь. кордон
- волинь. патрульна поліція
- волинь. поліція
- Волинь. самогубство
- волинь24
- Волиньбаскет
- Волиньвугілля
- Волиньгаз
- Волиньгаз збут
- Волиньелектрозбут
- волиньліс
- Волиньобленерго
- волиньрада
- волиняин
- волиняни
- волинянин
- волинянка
- волиьн
- Волі
- волкер
- волкова
- Волноваха
- волнтери
- волога
- Володимир
- Володимир Бондар
- Володимир Лис
- Володимир Путін
- володимир_гройсман
- володимир_гунчик
- володимир_мурашкевич
- володимир-волинськи
- Володимир-Волинський
- володимир-волинський район
- володимир-волинький
- володимирська
- Володимирщина
- Володир-Волинський
- волонтер
- волонтери
- волонтерка
- волонтерство
- Волошенюк
- Вольвач
- Воля
- Воля Любитівська
- ВООЗ
- Воробйова
- ворожі цілі
- ворожіння
- воротар
- воротнів
- Воротнівське лісництво
- Ворскла
- ВОУЛМГ
- вп
- впливові
- ВР
- врожай
- вроцлав
- Вроцлав квиткові термінали
- ВРУ
- вручення
- вручення дипломів
- Вселенський Патріарх Варфоломій
- Всесвітній день ходьби
- всеукраїнські ігри
- всихання
- всихання лісів
- всихання_дерев
- встановлення особи
- встановлення світлофора
- вступ
- вступ до НАТО
- вступ у ЄС
- вступ_2017
- вступна кампанія
- вступники
- втеча
- втеча_з_країни
- втонув
- втопився
- вторгнення
- вторгнення в Білорусь
- вторгнення Москви в Україну
- втрата
- втрати
- Вуєць
- вузи
- вулик
- вулиці
- вулиця
- вулкан
- Вусенко
- вчені
- вченні
- вчителі
- вчитель
- вчителька
- вшанування
- вятрович
- вячеслав шевчук
- Гаага
- габаритно-ваговий косплекс
- газ
- газ за рублі
- газета
- газета_День
- газове родовище
- газопостачання
- газопровід
- газпром
- гайдамаки
- Гайтана
- Галамазда
- Галан
- галерея
- галерея_мистецтв
- галина конах
- Галкін
- галузія
- Галькевич
- гамма_фон
- гандбол
- Ганзера
- Гань
- гапетит.
- гаражі
- гаражний_розпродаж
- Гаразджа
- гарант безпеки
- гарантії безпеки
- гарвард
- Гарік Кричевський
- Гармидер
- гаряча вода
- гаряча_вода
- гаряча_лінія
- гарячавода
- гасіння
- гастролери
- гастролі
- гастрономічний фестиваль
- гастрофіброскоп
- гаубиці
- гвинтівки
- Гейтс
- гелікоптер
- гемодіаліз
- Генасамблея_ООН
- Гендерна_група
- гендиректор
- генеологія
- генерал
- Генеральний штаб
- Генерація успішної дії
- генетика
- генконсульство
- генконсульствоПольщі
- геноцид
- Генштаб
- генштаб ЗСУ
- географічний центр
- геокадастр
- георгіївська стрічка
- георгіївська_стрічка
- георгіївські_стрічки
- гепатит
- гепатит А
- Герасим'юк
- герасимчук
- Геращенко
- Герман
- герої
- Героїв УПА
- героїв_майдану
- героїзм
- герой
- Герой_України
- Героям_небесної_сотні
- герта
- Герус
- гетто
- гибель
- ГІбляк
- гібридна_війна
- Гіві
- гівно
- гідрометцентр
- гім
- гімн
- гімн України
- гімназія
- гімнастика
- гімнастка
- гімнастки
- Гінайло
- гінеколог
- гіперзвукова ракета
- гіперзвукове озброєння
- гіпермаркет
- гіпертоніки
- гірка полонка
- Гірка_полонка
- Гіркін
- гірлянда
- гірники
- Гітлер
- гітлерівці
- Глазунов
- Глинюк
- глушець
- Гнатів
- Гнідавська
- Гнідавський цукровий завод
- Гнідавський_цукровий_завод
- гнідавськийзавод
- Гобл
- годинник
- Гокінг
- гол
- голишів
- голлівуд
- Голоби
- голобородько
- голова
- Голова ОДА
- голова_банку
- голова_дфс
- Головань
- Головін
- головний санітарний лікар
- головні_болі
- голод
- голод як зброя
- Голоднюк
- голодомор
- голодування
- голокост
- голомша
- Голос
- Голос країни
- голос_країни
- голос.діти
- голоси
- голоскоков
- голосування
- голуб
- голядинець
- Гомель
- Гомонець
- Гонтарева
- гончаренко
- гопак
- горазджа
- горбатюк
- Горбачов
- Гордійчук
- Гордіюк
- Гордон
- горенко
- гори
- Горик
- горичів
- Горі
- горілка
- горілчана_продукція
- горіх
- городище
- Горопевшек
- гороскоп
- Горохів
- горохів. замерз
- Горохівський_лісгосп
- горохівчанка
- Горохівщина
- горскоп_на_день
- госпіталізація
- госпіталь
- госпітальні_округи
- гості
- Гостомель
- готель
- готель світязь
- Гпзпром
- гпу
- грабіж
- грабіжник
- грабіжники
- Грабко
- грабовський
- град
- Градова
- гральний_заклад
- гральні автомати
- граната
- граната_Волинь
- граната_Луцьк
- гранати
- гранатомет
- гранатомети
- гранич
- грант
- графік
- графік роботи
- ГРВІ
- Гребанюк
- Гребенюк
- гребля
- греко_католицька_церква
- Греція
- гриб_глива
- гриби
- грибний сезон
- грибні уроки
- гривня
- Григорій Аркушин
- гримчак
- Гриневич
- грип
- Грицак
- Гриценко
- Грицюк
- гроза
- грози
- Гройсман
- громада
- громади
- громадська_рада
- громадське радіо
- громадський транспорт
- громадські слухання
- громадські_роботи
- громадяни
- громадянин_США
- громадянство
- громадянський резерв
- Громик
- Гронович
- гроцсман
- гроші
- гроші.
- грошы
- ГРУ
- грузини
- грузія
- Груник
- грунт
- Грушевський
- Грушевського
- гряда
- губин
- Губницька
- Гузар
- Гузь
- Гуковиця
- гуманітарна допомога
- гуманітарний конвой
- гуманітарний коридор
- Гуменюк
- гумконвой
- Гунчик
- гурт
- гуртожиток
- гуртожиток. Луцьк
- гусєв
- Гута Ковельська
- Давиденко
- ДавняКазка
- Дагестан
- далекобійник
- Данило Гайдамаха
- Данильчук
- Данилюк
- дані
- данілов
- данія
- даньшина
- Дара Корній
- дарій
- дата
- дати
- дах
- Дацюк
- дачне
- дачники
- дачні масиви
- даша ульянова
- ДБР
- дверні_ручки
- двійник
- двійнята
- дворовий_футбол
- Дворський
- Дебальцеве
- дебати
- дебош
- дебошир
- деда
- Дейна
- декан
- Деканоїдзе
- декларації
- декларація
- декларування
- декомунізація
- декрет
- делегація
- Делі
- дембель
- демобілізація
- демографічна криза
- демократія
- демонтаж
- демонтували
- Демчук
- денацифікація
- Дендеберін
- Дендіберін
- Дендібєрін
- День
- день вишиванки
- день вчителя
- день добровольця
- День Європи
- день жалоби
- день захисника україни
- день захисту дітей
- День кар'єри ЄС
- День Конституції
- День Конституції України
- день матері
- день медика
- день митника
- день міста
- день народження
- день незалежності
- день пам’яті та примирення
- день перемоги
- День Прапора
- День примирення
- день спорту
- День_батька
- День_бухгалтера
- день_відкритих_дверей
- день_вчителя
- День_Героїв
- день_гідності
- день_захисника
- День_захисту_дітей
- день_ЗМІ
- день_знань
- День_йоги
- день_матері
- День_медика
- день_міста
- День_молоді
- день_народження
- день_незалежності
- День_пам'яті
- день_писемності
- день_прапора
- день_працівника
- День_прикордонника
- День_примирення
- День_скорботи
- день_шахтаря
- деньнародження
- деокупація
- Департамент
- депозит
- депортація
- депутат
- депутати
- депутати-"зрадники"
- депутатська недоторканість
- дерева
- деревина
- деревообробники
- державна зрада
- державна мова
- державна_фіскальна_служба
- державний переворот
- Держаудитслужба
- держбюджет
- держбюждет
- держгеокадастр
- Держдума
- держекоінспекція
- держзрада
- держлісагенство
- держприкордонслужба
- Дерно
- десантники
- дефлімпіада
- дефлімпійці
- дефолт
- децентралізація
- джавеліни
- джаз-фест
- Джазовий_фестиваль
- Джамала
- джекпот
- Джен Псакі
- джерела
- джерело
- джерело_Святої_Анни
- джерело_смороду
- Джигурда
- джий-джитсу
- джиперс_криперс
- джиу_джитсу
- джиу-джитсу
- Джо Байден
- джокер фест
- Джон Болтон
- джордан
- Джошуа
- дзвіниця
- Дзвінка_Матіяш
- дзвінниця
- дзвонарство
- дзиґа
- дзідзьо
- Дзюба
- дзюдоїсти
- дики свині
- диктатор
- диктатор путін
- Динамо
- диня
- дип
- диплом
- дипломат
- дипломати
- директор
- директорка
- дирофіляріоз
- дисертація
- дистанційна робота
- дитина
- дитина-сирота
- дитсадки
- дитсадок
- дитяча_залізниця
- дитяче_євробачення
- дитячий садок
- дитячий табір
- дифтерія
- диякон Луцьк
- діамант
- діаманти
- Діброва
- дівчата
- дівчина
- дівчинка
- Діденко
- дідусь
- дікінсон
- діти
- діти_війни
- діти-переселенці
- Дія
- Дмитро Гершензон
- дмитро комаров
- днз
- Дні польського кіно
- дні_народження
- Дніпро
- Дніпропетровщина
- днк
- Днобас
- днори
- ДНР
- доба
- доба на донбасі
- добкін
- добриво
- доброволець
- добровольці
- довголіття
- довідка про приписку
- довічне
- додатковий потяг
- додаткові вагони
- додаток
- Додон
- доктор_звук
- документальний фільм
- документи
- долар
- долари
- долариї
- Долина_нарцисів
- дольськ
- Доманове
- доманська
- домашнє насильство
- домогосподарка
- Донбас
- донбас-арена
- Донецьк
- Донецька область
- донецькі бойовики
- донорство
- донорська кров ковель
- Донськой
- донька_воїна
- доплати
- допомга
- допомога
- допрем'єрний показ
- допризовники
- дорога
- дороги
- дорожники
- дорожній_знак
- дорожня_поліція
- дорожня_розмітка
- доросині
- Дорошенко
- дослідження
- доступні_ліки
- Досутпні_ліки
- дот
- дотації
- доходи
- дошка
- дошки
- дощ
- дощі
- дпомога
- дпрч 3
- драбина
- драбинко
- драг-рейсинг
- драма
- драмтеарт
- Дрелінг
- дровітня
- Дрогобич
- Дроздов
- дрон
- дрон-камікадзе
- дрони-камікадзе
- дронов
- дротаверин
- Друга ріка
- друга світова війна
- друга_ліга
- друга_ріка
- Друга_світова_війна
- дружина
- друзі просять
- ДСНС
- ДТП
- дтп підгайці
- дуб
- дубечне
- дуби
- дубина
- Дубище
- дубінсьикй
- дубінський
- Дубневич
- дубнівська
- дубове
- дуда
- Дудік
- Дудка
- дума
- Думанський
- дурні
- духнич
- Душечкіна
- ДФС
- Дчинець
- ДЮСШ
- дядя жора
- дядя_жора
- е-квитки
- Е-квиток
- евакуатор
- евакуація
- Еверест
- евтаназія
- Едуард Бєльський
- екзорцизм
- екзотика
- екіпаж
- екоінспекція
- екологія
- економіка
- економія
- екснардеп
- ексорт нафти
- експер
- експеримент
- експерт
- експерти
- експонати
- експорт
- експорт зерна
- екстрасенси
- екстремал
- екстрена служба
- електрика
- електрички
- електродвигун
- електроенергії
- електроенергія
- електрокар
- електрокоагулятор
- електромобілі
- електронне декларування
- електронний_квиток
- електронні довідки
- електронні рецепти
- електронні сигарети
- електропостачання
- Електротермометрія
- електротранспорт
- елетронна
- еліна світоліна
- ембарго
- емд
- емігранти
- емігрантки
- еміграція
- енергоаудит
- енергоблок
- Енн Стефанек
- епідемія
- Епіфаній
- естерсунд
- Естонія
- етно-фестиваль луцьк
- етнофестиваль
- ЄБРР
- Єва Крощук
- євро
- євробаскет
- Євробачення
- Євробачення - 2019
- Євробачення-2018
- Євробачення2017
- Євробачення2018
- євробляхи
- Єврокомісія
- Євроліга
- єврономери
- єврооблігації
- Європа
- Європа вислала російських дипломатів
- Європейська_олімпіада
- європейські надгробки
- Євтушик
- єгипет
- Єлизавета ІІ
- Єлісеєва
- єпархія
- Єпіфаній
- єрусалим
- Єршова
- ЄС
- Єфремов
- Жабче
- Жадан
- жарти
- Жартовська
- жасмин
- Жданов
- Жебрівський
- жек
- жеребкування
- жертва
- живодерка
- Жидичин
- Жизневський
- Жириновський
- житло
- житомир
- Житомирщина
- жінка
- жінки
- жкг
- ЖКП
- жнива
- жовта зона
- жовтень
- Жолоб
- жорстокість
- Жулинський
- жуляни
- Жуніч
- журавичі
- Журба
- журналіст
- журналісти
- журналістика
- журналістка
- з україною в серці
- забіг
- заболоття
- заборгованість
- заборогованість
- заборона
- заборона реклами
- заборона_в'їзду
- заборона_Вконтакте
- заборона_сайтів
- заборони
- забрудненість
- забруднення
- забудовник
- Забужко
- завацька
- Завидів
- завод
- Завокзальний
- загбель
- загибель
- загиблий
- загиблий_Герой
- загиблі
- загиблі_АТО
- загинув_волинянин
- загинули
- загорання
- загорання авто
- загорецька
- загроза
- загубився
- Задерецький
- Задзеркалля
- задорожнбк
- Задорожний
- зажинки
- зайцев
- Зайцева
- Закарпаття
- заклади_освіти
- закладки
- закладчики
- закон
- закон про мову
- закон про олігархів
- закон про освіту
- закон_пенсії
- закони
- законопроект
- законопроекти
- закриття
- закупи
- закупівлі
- закупівля
- Залдостанов
- залізний купол
- Залізниця
- залізничнй транспорт
- залісці
- замах
- замети
- заміжжя
- замінування
- замкнена квартира луцьк
- замовне вбивство
- замок радзивілів
- Замок_Любарта
- заморозки
- зань
- заняття
- Запад-2017
- запаси нафти
- запит
- заповідна_зона
- заповітна
- Запоріжжя
- Запотоцький
- заправка
- заправки
- заробітна_плата
- заробітчани
- заробітчанин
- заробітчанство
- зарплата
- зарплата митників
- зарплати
- засідання
- заслужений_донор_України
- засоби хімзахисту
- застава
- застрелили чоловіка
- заступник
- затопило
- затор
- затриманий
- затриманння
- затримання
- Затурці
- зауваження
- захаращеність
- Захарченко
- Захарчук
- захворювання
- захисники
- захист
- захист прав
- захід
- захід України
- захід-2017
- захід2017
- західна техніка
- західний_центр
- Західні Балкани
- заходи
- захопили
- захоплені_судна
- заява
- заяви
- збереження
- Збитки інфраструктури України
- збій
- збільшення
- збір ягід
- збір_коштів
- збір_підписів
- збірка
- збірна
- збірна дівчат
- збочинець
- зброя
- збут
- звання
- звернення
- звинувачення
- Звитяга
- звільнення
- звіринець
- звірівське лісництво
- звірства під Києвом
- звітність
- ЗВТ
- звязок
- згвалтування
- згорів_автомобіль
- згуба
- здача
- здача зброї
- здачакрові
- здолбунів
- здомишель
- здоров'я
- здоров’я
- Здрок
- зед
- зек
- зеленська
- Зеленськи
- Зеленський
- земан
- земельна ділянка
- земельна реформа
- землетрус
- землетрус_Мексика
- землі
- земля
- земля в оренду
- зеніт
- зенітні комплекси
- зерно
- зима
- Зимне
- зимнівська громада
- зимовий_час
- Зідан. Ле Пен
- зік
- зінкевич
- Зінченко
- зір
- Зірка
- зірки
- зіткнення
- зйомки
- зйомки фільму
- злам
- зле за кермом
- злива
- зливи
- злидні
- зловмисник
- зловмисники
- злодії
- злодії знеструмлення села
- злодій
- злотий
- злочин
- злочинец
- злочинець
- злочини
- злочинність
- зм
- змагання
- ЗМІ
- змії
- зміїнець
- зміна
- зміни
- змія
- знаки_зодіаку
- знахідка
- знеструмлення
- знеструмлення_сіл
- знижка
- знижки
- зник
- зникволинянин
- зникла
- зниклі
- зникнення
- зникчоловік
- знищені в Донецькій області
- знищення
- ЗНО
- зно_2017
- ЗНО-2018
- ЗНО2020
- знущання
- зодіак
- зозуля
- золбунів
- золота тераса
- Золотарьов
- золото
- зона відчуження
- зони карантину
- зонування
- зоозахисники
- зоопар
- зоопарк
- зорепад
- Зорін
- зоря
- зрада
- зризунинаВолині
- зрк "Бук"
- ЗРК "Куб"
- зрк "тор"
- ЗРК NASAMS
- Зробимо Луцьк чистим
- зростання
- зросте
- ЗС РФ
- ЗСУ
- зсув
- зуби
- зубр
- зупинка
- зупинки
- зустріч
- зцілення
- Іван Драч
- Іван Пасевич
- Іван Чернецький
- Іван_Алєйнік
- іван_шевчук
- Івана_Купала
- Іваничі
- іваничівська громада
- Іваничівська ОТГ
- Іваничівський
- івано-франківськ
- Іванова
- іванчиці
- Івахів
- Іво Бобул
- івшина
- Ігор Єремеєв
- Ігор Квач
- ігор кузин
- ігор поліщук
- іграшки
- ігри воїнів
- ігри_нескорених
- ігроманія
- ізраїль
- Ізюмський район
- ікона
- ікона святого Миколая
- ікони
- Іл-80
- іменини
- імміграція
- імпічмент
- імпічмент президента
- імпорт
- імпорт газу
- імпорт нафти з Росії
- імунітет
- інвалід
- інваліди
- інвестиції
- Інгушетія
- індивідуальні_теплові_пункти
- індіанці
- індійський штам COVID
- індія
- Інженер
- Іній
- інна_гайворонська
- інновації
- іноземець
- іноземна мова
- іноземні авто
- іноземці
- іноземцікупують
- іномарка
- ІнРен
- інстаграм
- інститут
- Інститут харчових технологій
- інститут_Нацпам"яті
- інстиут_Національної_пам'яті
- інсульт
- Інтер_Атлетика
- Інтерв'ю
- інтернет
- інтернет-кафе
- Інтерньюз_Україна
- інтерпол
- інтерсіті
- інфекційна
- інфляція
- інфраструктура
- ірина видрик
- Ірина Федишин
- ірландія
- Ірма Вітовська
- іронія долі
- Ірпінь
- іспанія
- іспит
- історична пам’ятка
- історія
- історія_україни
- італія
- їдальня
- їжа
- йоббік
- Йованович
- йоганніс
- кабаєва
- кабаненко
- кабани
- Кабмін
- кава
- кавальєро
- кавер
- кавун
- кадирівці
- Кадиров
- кадировці
- кадри
- казанський
- казарми
- казахстан
- казино
- каладзе
- календар
- Калинівка
- Калінінград
- Каліщук
- Калмикія
- камаз
- камери
- камериспостереження
- камериспостереженняуЛуцьку
- Камінь-Каширський
- Камінь-Каширщина
- канабіс
- Канада
- канал
- канали
- каналізація
- кандидати
- канікули
- Канни
- капелан
- капелани
- каплиця
- каплін
- капоніри
- капранови
- капуста
- карабах
- карантин
- карантин польща
- карантин. луцьк
- карантинні зони
- караоке
- Каратницький
- карбування монет
- Кардаш
- кардіолог
- карикатура
- кароль
- карпати
- Карпінський
- Карпомиз
- карпус
- карпюк
- карта дій
- Карта поляка
- картини
- картка
- картка лучанина
- картки
- картографія
- картопля
- карусель
- каса
- Касарда
- Касем
- касетні боєприпаси
- касільяс
- каскадери
- каски
- касовий_апарат
- кастет
- каталонія
- катастрофа
- Катерина Лозовенко
- катеринюк
- католицька пасха
- Катрусин кінозал
- катюша
- Катя_Литкіна
- кафе
- Каховка
- Качинський
- квадроцикл
- квадроцикли
- кваліфікація волинь
- Квартал 95
- квартира
- квартиранти
- квартири
- Кварцяий
- Кварцяний
- Кватирко
- квест
- квитки
- квіти
- квітковий_ринок
- Квітневе
- квоти
- Квятковський
- кдб
- Кеда
- керівник
- кив
- кива
- Київ
- Київ_Варшава
- Київ_Ковель
- київ-ковель
- київ. гуртожиток
- Київщина
- киїів
- кирил
- Кирило Гундяєв
- киричук
- кисень
- Кислиця
- китай
- китайці
- кіа
- кібератака
- кібератаки
- кібербезпека
- кіберполіція
- кіберполіця
- кібершпигунство
- кіборги
- ківа
- Ківерці
- ківерцівська
- ківерцівськийрайон
- ківерцівщина
- ківерчанин
- Кідрук
- кікбоксинг
- кількість
- Кіндер
- кіно
- кінологічний центр
- кіноперегляд
- кінопоказ
- кінотеатр
- кінотеатр "Батьківщина"
- кінофестиваль
- кінь
- кіоск
- Кіпіані
- кіпр
- кір
- Кіріл
- Кістіон
- кіт
- Кічкарівська
- кішка
- кладовища
- кладовище
- Клевань
- кликун
- Клименко
- Климець
- Климук
- Кличко
- клімат
- Клімкін
- Клімчук
- клініка
- клінічна смерть
- клінічна_лікарня
- Клінтон
- кліп
- кліпси-окуляри
- Клітицьк
- кліщ
- кліщі
- клуб
- кму
- кндр
- книга
- книгарня
- книгарня_Є
- книгарня_планета
- книги
- книги_білінгви
- кнопкодавство
- кну
- княгининівська громада
- Княгининок
- княжна
- Князєв
- князівський бенкет
- Князівський_бенкет
- Князывський_бенкет
- кобзар
- кобзарство
- кобзарське_віче
- Ковальчик
- Ковель
- Ковель_Хелм
- Ковель_Хемл
- Ковель. Маркевич
- ковельветсанзавод
- Ковельська
- ковельська міська рада
- ковельське мтмо
- ковельський ветсанзавод
- ковельський медколедж
- ковельський район
- Ковельський_ветсанзавод
- ковельчанин
- ковельчанки
- ковельщина
- ковзканка
- ковід
- ковідний паспорт
- ковлеь
- кого не візьмуть
- коефіцієнти
- Кожанов
- Козак
- козацькі могили
- Козацькі_забави
- козлів
- Козлюк
- кокаїн
- Кокотюха
- колаборанти
- колабораціонізм
- коледж
- Колки
- Колківська_республіка
- Колодяжне
- коломійчук
- коломойський
- колонія
- колонки
- колос
- Колпитів
- колядка
- кома
- командир
- командно-штабні навчання
- Комаристий
- комаровський
- коментарі
- коміки
- комісія
- Комітет_виборців_України
- Коморські-острови
- компенсація
- компроміси
- комуналка
- комунальне_підприємство
- комунальники
- комунальні послуги
- комунікативістика
- Конго
- конгрес
- Кондзелевич
- конкурс
- конкурс_громадські_ініціативи
- конкурс_співців
- конопля
- Коноплянка
- консервація
- Констанкевич
- констрабанда_сигарет
- консульство
- контрабанда
- контрабанди
- контракт
- контракти
- контролери
- контроль
- контроль_депутатів
- контрфакт
- конференція
- конференція донорів
- конфлікт
- концерт
- конякіна
- копачівка
- копачівська громада
- копачівське благочиння
- корабель
- кораблі
- корбан
- кордон
- кордони
- корецький
- Корея
- Корж
- корнієнко
- Корнійчук
- коробчук
- коровай
- корови
- короїди
- королева Єлизавета II
- коронавіру
- коронавірус
- коронавіус
- коронавріус
- Корсак
- корсині
- кортеж
- корупція
- косино
- косів
- космос
- костел
- Костенко
- котел
- котельня
- коти
- котрабанда
- Коуч
- коханка Путіна
- кохання
- Коцан
- Кошарук
- Кошель
- кошенята
- Кошовий
- кошти
- коштовності
- кп
- кпп
- Кравець
- Кравченко
- Кравчук
- кравчука
- крадене авто
- крадіжка
- крадіжка лісу
- крадіжка любешів
- крадіжка.Горохівщина
- крадіжки
- крадіжки газу
- крадії
- крадії_лісу
- крадій
- крадужки
- краєзнавець
- краєзнавчий
- краєзнавчий_музей
- краєзнавчий_УПА
- краіжка
- країни
- країни "Великої сімки"
- країни G7
- кралюк
- краматрськ
- краніостеноз
- краса
- Краснодарський край
- красуня
- крах
- кращий студент
- кращий_гол
- кращі_ініціативи
- креди
- кредит
- кредити
- кредити_у_валюті
- крейсер "Москва" пошкодження
- крейсер москва
- кремація
- кременець
- кремінь
- кремль
- Кресак
- кривий вал
- кривий ріг
- Кривий рік
- Кривий_Вал
- кривіцький
- Крижановська
- крижівка
- Криклій
- крилаті ракети Нептін
- Крим
- криміал
- Кримінал
- кримінал. Горохів
- криптоферма
- кришнаїти
- крокодили
- крокуси
- кропивницький
- крулько
- крупа
- Крупенич
- Кубів
- кубілюс
- кубок
- кубок_світу
- Кубок_України
- Кузьмінський
- Кулакової
- кулеба
- Кулик
- Куликів
- куликов
- куликовичі
- кулінарія
- Куліш
- Культура
- культурно-просвітницький_заклад
- Кульчин
- кум
- КУН
- куницький
- Купайла
- купити ялинку
- купівля
- купівля землі
- купівля обладнання
- купівля_землі
- купюри
- Кург
- курди
- Курзун
- Курило
- куріння
- курйоз
- курйози
- Курков
- курорт
- курс
- курс валют
- курс_валют
- курс_долара
- курсавтобуса
- курсанти
- курсвалют
- курси
- курси програмування
- курсування поїздів
- курці
- курятина
- кути
- Кутового
- кухня
- кучер
- кучинський
- Кучма
- Кушнір
- Кшиштоф Савіцькі
- кювет
- лабораторія
- лава
- лавина
- лавки
- Лавренюк
- Лавринович
- Лавров
- лагідна українізація
- ладомир
- лайки
- ландшафт
- ланцюг
- ланцюжок
- ланч
- Лапін
- Лариса Середяк
- ласка
- лгбт
- Ле Пен
- Ле Пн
- лебеді
- лебідь
- лев
- левченко
- легалізація
- легіон
- легка атлетика
- легка_атлетика
- легкоатлети
- легкоатлетика
- легкоатлетична_естафета
- легковик
- легковики
- лекція
- Леміщак
- Леонід Каденюк
- Леонід_Кантер
- леонід_стефанович
- Лепс
- лептоспіроз
- Лесик
- Лесь_Танюк
- Лесюк
- Леся Українка
- Леся_Українка
- летальна зброя
- летовище
- Лешенко
- Лещенко
- лє
- липень
- Липини
- Липинський
- липучки
- лис
- Лисичанськ
- листопад
- литва
- литвин
- Литовеж
- лицарі
- Лівія
- ліга сміху
- ЛІга чемпіонів
- Ліга_Європи
- ліга_сміху
- лідер
- лідер опозиції
- лідери
- лікар
- лікарі
- лікарні
- лікарня
- лікарня.черги
- лікарняний
- ліквідація
- ліки
- лікування
- Лікування_за_кордоном
- ліміти
- Лінда Томас-Грінфілд
- ліосировина
- ліпіни
- ліс
- Лісабон
- лісівники
- лісництво
- лісова охорона
- лісова хорона
- лісова_пожежа
- лісові пожежі
- лісові_дороги
- лісопродукція
- літак
- літак "судного дня"
- літаки
- література
- літній час
- літній_період
- літо
- Літовченко
- Літогощі
- літургія
- ліфт
- ліфти
- ліцеї
- ліцей
- ліцей-інтернат
- ліцензії
- ліцензія
- лічильники
- Ліщинська
- ЛНР
- ЛНТУ
- Лобачівка
- Логвинюк
- лойко
- локачанка
- Локачі
- локдаун
- локомотив
- Лоліта
- Ломаченко
- Лондон
- лось
- лотерея
- лото-забава
- лоторея
- ЛПЕ
- ЛПК
- Лубківський
- луганськ
- Луганщина
- Лужний
- луйьк
- Лукас
- Лукаш
- Лукашенко
- луків
- Лускунчик
- Луценко
- Луцик
- луцк
- луцчани
- луцьк
- Луцьк вартість проїзду
- Луцьк День міста
- Луцьк муніципальна варта
- луцьк сурогат
- луцьк тролейбуси
- Луцьк_погода
- Луцьк-Ковель
- Луцьк-Львів
- Луцьк-Радехів_Львів
- луцьк-рівне
- Луцьк-Хотешів
- Луцьк. кримінал
- луцька
- луцька гімназія
- луцька клінічна лікарня
- луцька міська клінічна лікарня
- Луцька міська рада
- Луцька тюрма
- Луцька_тюрма
- Луцькводоканал
- луцьке сізо
- Луцькенерго
- луцькиепло
- луцький виш
- Луцький геріатричний панесіонат
- луцький загін
- луцький замок
- луцький зоопарк
- луцький міськрайонний суд
- Луцький пологовий
- луцький прикордонний загін
- Луцький район
- Луцький_замок
- луцький_кликун
- луцький_район
- луцькийпарк
- Луцькийректор
- луцькі медзаклади
- луцькі школи
- луцькі_студенти
- луцькімаршрутки
- луцькк
- Луцькрада
- луцьксвітло
- Луцькспецкомунтранс
- Луцьктепло
- Луцьку
- лучани
- лучанин
- лучанка
- Луческу
- луьк
- Лшенко
- Львів
- львів-луцьк
- львів'янин
- львів'янка
- Львівська
- львівська залізниця
- львівська_психлікарня
- Львівщина
- львівянин
- Львочкін
- льотчики
- Любешів
- Любитів
- люблинець
- люблін
- Любомиль
- Любомильщина
- Любомир_Гузар
- Любомль
- любомльщина
- Любохини
- люд
- люди
- люди з інвалідністю
- людина
- людмила_бубенова
- людмила_стемковська
- людські_рештки
- люк
- лютий
- лялкарі
- лямбліоз
- Ляснюк
- ляшенко
- Ляшко
- Ляшук
- м'янма
- м'ясо
- магазин
- магда
- магістр
- магістратура
- магнітна буря
- магнітна_буря
- магнітні_бурі
- Мажор
- Мазін
- Мазур
- мазурик
- Мазурок
- майбутє
- майдан
- майданівці
- майданчик
- майданчик спортивний_майданчик
- майно
- майно дружини Медведчука
- майор
- майстер-клас
- майстри
- мак
- Макаров
- Макгрегор
- МакДональдз
- македонія
- маккейн
- Макрон
- макрон переміг
- Макс Барських
- Макс Кідрук
- Максим Гринчишин
- Максим Киричук
- максим кушнірук
- максим степанов
- максим ткачук
- Максим_Ткачук
- маленькі_Нідерланди
- малозабезпечені
- малофєєв
- малюки
- малюнки
- Малютіна
- мамай
- мандат
- мандрівки
- Мандрівний_вішак
- Маневичі
- маневичі. цнап
- Маневиччина
- Маневиччна
- манецький_ліцей
- манікюр
- маніпуляція
- Манчестер
- Мар’їна
- Мар’янівка
- маразм
- марафон
- марафон_йоги
- Марина Єщенко
- марихуана
- марійка борисова
- маріонетка
- маріуполь
- Марія Хурсенко
- марка
- маркетмейкер
- марки
- Маркова
- Маркушин
- Марлос
- марс
- Мартиненко
- Мартинюк
- Маруняк
- марченко
- Марчук
- марш
- марш патріотів
- Маршаллові_острови
- маршрут
- маршрути
- маршрутка
- маршрутки
- масаж
- Маск
- маски
- матвєєва
- Матвієнко
- Матвійчук
- матері
- мати
- мати-героїня
- Матіос
- матір
- матушки
- маунтенбайк
- маунтінбайк
- махаурі
- машина
- машини
- машинобудування
- МВС
- МВФ
- МЕА
- мед
- медалі
- медаль
- Медведєв
- Медведчук
- Меджліс
- медзаклади
- медики
- Медицина
- медична реформа
- медичне обладнання
- медичний коледж
- медичний_коледж
- медичний_пункт
- медичні
- медіа
- медіахолдинг
- медобладнання
- Медовий Спас
- Медовий_спас
- медогляд
- медпрепарати
- медсестра
- Мейвезер
- меладзе
- Меланки
- Мелітополь
- мельник
- мем
- меморандум
- Меморіал
- меморіальна дошка
- меморіальна_дошка
- меневичі
- мер
- мер Садовий
- мер_аргентини
- мережа "АТБ"
- меридіан
- Меркель
- МеркельМінські_угоди
- мерседес
- мертве
- метання
- метеозалежність
- метро
- механізм верховенства права
- мзс
- Ми-17
- мигалки
- мийні засоби
- микичак
- Микола Мартинюк
- Микола Шум
- Микола_Романюк
- микола_смокович
- Микола_Якимчук
- Миколаїв
- миколай
- милованов
- минай
- мир
- Мирка
- Мирні жителі
- мирні переговори
- Мироненко
- Миронюк
- мирослава_кушнір
- миротворці
- мисливці
- мистецтво
- мистецьке_свято
- митник
- митники
- митниця
- митні_платежі
- митрополит
- митрополит Павло
- Михаїл
- михайло єрлін
- михайло микулін
- михайло шпір
- михайло_імберовський
- Михалик
- Мишко
- Мишковець
- мишовиднігризуни
- Міг
- мігранти
- міграційна служба
- міграційна_служба
- міграція
- мідний кабель Іваничі
- міжнародний церковний трибунал
- міжнародний_день_людей_похилого_віку
- міжнародний_обмін
- Міжнародні_змагання
- мілина
- Мілошевич
- мільйонер
- мільйонери
- мільярд гривень
- мільярдери
- мін'юст
- міна
- Мінагрополітики
- мінагрополіткик
- Мінгареллі
- Міндоходи
- міни
- міни уповільненої дії
- мінімалка
- мінімальна_заробітна_плата
- міністерство
- Міністерство фінансів Франції
- міністр фінансів Росії
- Міністр фінансів України Сергій Марченко
- Міноборона РФ
- міносвіти
- мінсоцполітики
- мінськ
- Мінський район
- мінські переговори
- мінфін
- міс
- Міс_Волині_2017
- міс_принцеса
- міст
- містер
- місто Буськ
- місто_мрії
- місце
- місцеві_вибори
- міська рада
- міський голова
- міськрада
- місюра
- місяцехід
- місяць
- місячне_затемнення
- мітинг
- мішок
- мішок картоплі
- млинці
- мма
- мобілки
- мова
- мовлення
- мовні квоти
- могили
- Могіль
- модель
- модерн_експо
- модернізація
- Модеста Левицького
- модний_показ
- МОЗ
- мозок
- мойка_машин
- мойсюк
- Мокренко
- Молдова
- молебень
- молитовне_стояння
- молода картопля
- молодики
- Молодіжна_платформа
- молодіжна_рада
- молодь
- молоко
- молоковоз
- молот
- молочна ферма
- мон
- монастир
- Монатик
- Монатік
- монета
- монети
- монетизація
- монетизація_субсидії
- моноліт
- монумент Небесної Сотні
- мопед
- морваі
- моржі
- мороз
- морози
- Морочковська
- моряки
- мосійчук
- мосінка
- Москаль
- МОСКАЛЬ_НЕКРАСІВИЙ
- москва
- москвич
- московське
- Московського вищого військового командного училища
- мотор
- Моторола
- моторсіч
- мотоцикл
- мотоцикліст
- мотоциклісти
- мотузковий парк
- мочульський
- Мошкун
- мрт
- музеї
- музей
- музей_ікони
- музей-скансен
- музика
- музикант
- музиканти
- музична школа
- музичний вернісаж
- Мукачево
- мультик
- мультфільм
- муніципал
- муніципали
- муніципальна варта
- муніципальна поліція
- муніципальна_поліція
- муніцмпальна_поліція
- мурал
- мурал на Оболоні
- Мустафа Найєм
- мюнхен
- набережна
- набої
- Набрид
- набруска
- НАБУ
- навальний
- навігатори
- Навіз
- Навроцька
- навчальний рік
- навчання
- Наглядова_рада
- Нагорний
- нагорода
- нагородження
- нагороди
- награбоване
- надбавка
- надгробні плити
- надзвичайна ситуація
- надзвичайна_ситуація
- надточій
- Назаревич
- Назаренко
- найгірше_місто
- найда
- найстарший_українець
- наливайки
- наливайченко
- напад
- напад Росії
- нападники
- наполі
- напрямок
- нарада
- нарахування
- нардеп
- нардепи
- наркобізнес
- наркозалежність
- нарколабораторія
- наркомани
- наркотики
- наркоторгівля
- наркоторговець
- народження
- народжуваність
- народились
- народилось
- народилося
- народні_обранці
- нарцис
- наса
- Насалик
- населення
- насилля
- насильство
- насмерть
- наступ
- Настуся Абрамчук
- Настя Абрамчук
- Наталія Гуркіна
- наталія деденко
- НАТО
- наука
- науки
- науковець
- науковий центр
- науковці
- Наумчук
- науседа
- Нафанаїл
- нафта
- нафтобази
- нафтогаз
- нафтопровід
- Нахічеванська автономія
- Нацбанк
- нацгвардія
- нацгравдія
- нацизм
- нацисти
- націоналізм
- нацкорпус
- нацменшини
- Нацполіція
- нацрада
- начальник
- начальник_Держгеокадастру
- НБУ
- нвоволинськ
- НДР
- не буде води
- Не буде світла
- не_буде_світла
- неангели
- небезпека
- небезпечна іграшка
- небезпечні розваги
- небесний_легіон
- небіжка
- Невзоров
- невідома хімічна речовина
- негода
- Неділько
- Недопад
- недуга
- незаконна деревина
- незаконна зброя
- незаконне_отримання
- незаконне_переміщення
- незалежність
- незвір
- незрячі
- нейрохірургія
- нелегал
- нелегали
- нелегальний алкоголь
- нема світла
- немагарячоїводи
- немає світла
- немає_світла
- немасвітла
- немовля
- немовлята
- Немчанін
- Неплях
- неповнолітні
- неповнолітній
- неповнолітня
- неповторність
- непрацює
- непродуктивні
- нерухомість
- нетрадиційне весілля
- Нехаммер
- нечистоти
- нещасний_випадок
- нещастя
- Нижник
- Никитюк
- Никодим
- Нискогуз
- ні_цигаркам
- нідерланди
- ніж
- німеччина
- німченко
- Ніна_Романюк
- Ніфонт
- ніч
- ніч_музеїв
- нічна екскурсія
- нічна_екскурсія
- нічне-кіно
- нічний клуб
- нічні клуби
- нло
- Нобелівська_премія
- нова пошта
- новак
- Новарчук
- новволинськ
- новий магазин
- новий текст
- новий_ринок
- новий_рік
- новини
- Новини Волині
- новини_волині
- новини_луцька
- новиниЛуцька
- новиниУкраїни
- нові
- нові_виплати.
- нововвдедення
- нововведення
- нововлинськ
- Нововолинськ
- нововолинська
- нововолинська_шахта
- новонароджені
- новонародженні
- новорічні_свята
- Новосад
- нога
- ноги
- ножі
- ножове поранення
- нок
- нокаут
- номери
- номерник знак
- номерні знаки
- Ноняк
- Норвегія
- ноутбук
- нту
- нуйно
- об'єднання
- об'їзд
- обвал
- обвал мосту
- обвал стін
- обвалення_мосту
- обговорення
- обеліск Божих заповідей
- обенеж
- обенижі
- обеніж
- обійми
- обладнання
- Облапи
- облрада
- обман
- обман шахрай
- обмежений_рух
- обмеження
- обмеження_руху
- обмежувач_руху
- обміління
- обмін
- обмін полоненими
- образ
- ОБСЄ
- обслуговування
- обстеження
- обстірли
- обстріл
- обстріли
- обшук
- обшуки
- овадно
- овеча ферма
- овчаренко
- огида
- огієнка
- огляд
- огляд доріг
- оглядовий майданчик
- оголена дівчина
- оголошення
- огризко
- ода
- Одеса
- одеса-ковель
- одесса
- одещина
- одноразові гранатомети
- односторонній рух
- одруження
- ое
- ожеледиця
- озброєння
- оздоровлення
- оздоровлення дітей
- озера
- озеро
- озеро_Чорне
- Океан Ельзи
- Океан_Ельзи
- Оконськ
- окопи
- Оксана Марченко
- оксана_нікітюк
- Оксенчук
- Октисюк
- окупанти
- окупантів труять
- окуповане місто
- Олег Скрипка
- Олег Точинський
- Олейнікова
- олександр Луцик
- Олександр Савченко
- олександр тупицький
- олександр_зорін
- Олександр_Кваша
- Олександра Забіяка
- Олександра Ліпич
- Олександрійський патріархат
- Олена Кицан
- олені
- оленівка
- олень
- оленяча ферма
- Олеся Булах
- Олеся Ковальчук
- олика
- олігархи
- Олійник
- олімпіада
- олімпійський
- олімпійці
- олмпійська_підготовка
- Ольга Гайдучик
- Оля Полякова
- Омельчук
- Омелян
- Онищук
- онко
- онкодиспансер
- онкологічний_центр
- онкологічні хвороби
- онкологія
- онкохвора
- онкохворі
- онкохворі діти
- онкохвороба
- онкохвороби
- онлайн
- оновлення
- Онуфрій
- оон
- ООС
- ОП
- опалення
- опалення. сну
- опалювальний сезон
- опалювання
- оператор
- оператори
- операція
- опзж
- опитування
- опитування щодо війни
- опіки
- оплата
- оплата за газ
- оплот
- опляк
- Опоблок
- Опозиційний_блок
- опонент
- ОПОРА
- опромінення
- оптика
- Орбан
- орган
- органи
- організації
- орден
- орден_Княгині_Ольги
- ордени
- ОРДЛО
- оренда
- оренда квартири
- оренда_житла
- орендатори
- орієнтування
- оркестр
- орхідеї
- Осадча
- ОСББ
- осблуговування
- освіта
- освітлення
- освітня_реформа
- освітяни
- освячення пасок
- оселя
- Осівці
- Осіїк
- осійчук
- осінь
- оскар
- Оскар і рожева пані
- оскарження
- осквернення
- Осмаєв
- останні_новини_волині
- останні_новини_луцька
- останній дзвінок
- Остапук
- острів
- отг
- оторвальд
- отруєння
- отруєння_грибами
- отруйна вода
- отрута
- оун
- Офіс прокурора
- офіційні особи США і Європи
- оформленя_працівників
- охорона_здоров'я
- оцінка
- очільник
- ощадбанк
- п`яний за кермом
- п'єса
- п'яне водіння
- п'яний за кермом
- п'яний_водій
- п'яні
- п'яні_водії
- П'ятидні
- паб
- Павел
- Павелко
- Павлік
- Павло Гриб
- Павло Шеремета
- Павлова
- павлюк
- паводок
- падіння
- падіння з висоти
- паї
- пайфер
- пакет обмежень
- паливо
- Палиця
- палії
- паління
- паломниця
- пальне
- пам'ятник
- пам'ятник_Голокосту
- пам'ять
- панасюк
- панахида
- Панков
- Панчук
- паогода
- папа римський
- папа_римський
- Паперний
- папка24
- пара
- парад
- паразити
- паралімпіада
- паралімпійська збірна
- паралімпійці
- парасюк
- Паращій
- ПАРЄ
- парк
- паркан
- парки та сквери
- парковий волейбол
- парковка
- паркування
- паркувння
- парламент
- пародія
- партизан
- партизани
- партії
- партія
- партія_регіонів
- партнерство
- Парубій
- Пархом’юк.Семениш
- Пархомук
- Парчевський
- пасажири
- пасевич
- пасіка
- паски луцьк
- паспорт
- Паспорт України
- паспорти
- пасторт
- пасха
- Пасха великодній кошик поради
- патіо ді фіорі
- патріарх
- патріархія
- патрільна поліція
- патріоти
- патріоти_волині
- патріотичне татуювання
- патріотичний_фестиваль
- патрони
- патруль
- патрульа поліція
- патрульна
- патрульна поліція
- патрульна_поліція
- патрульний
- патрульні
- патрулювання
- пауерліфтинг
- пауза
- пахачук
- Пацаманюк.Маневицький_держлісгосп
- пацієнт
- пацієнти
- пашинін
- пашинський
- Пащенко
- пвк
- пдв
- ПДР
- пдф
- педагоги
- педофіл
- Пекін
- пекло 21 століття
- пенсії
- пенсійна реформа
- пенсійна_реформа
- пенсійний вік
- пенсійний_вік
- Пенсійний_фонд_України
- пенсіонер
- пенсіонери
- пенсіонерка
- пенсія
- Пентагон
- первісток
- переахунок
- перебіг_хвороби
- переведення_годинників
- перевезення
- Перевезенцев
- перевізник
- перевізники
- перевізникиЛуцька
- перевірка
- переворот
- переговори
- передача_даних
- перезавантаження альянсу
- переїзд
- перейменування
- перейменування_вулиць
- перекриття
- перекриття руху
- перекриття_руху
- перекриття_траси
- перемога
- Перемоги
- переможець
- переможці
- Перепеча
- перепоховання
- переправа
- перерахунок
- переробка
- перерозподіл
- пересадка
- переселенці
- переспа
- перехоплення
- перехрестя
- перинатальний_центр
- періодика
- персик
- перша ліга
- першачки
- перший тур виборів
- пес
- пестициди
- петарда
- ПетерМаркі-Зай
- петиції
- петиція
- Петренко
- петро біляшевич
- Петро Савчук
- Петро_Порошенко
- Петровець
- Петрочук
- Петько
- печатка
- печиво
- Пєрвоє апрєля – нікому нє вєрят!
- Пєсков
- пиво
- пилорама
- пилорами
- пиріжки
- Пирожик
- писанки
- письменники
- письменниця
- Південна Корея
- півень
- півмарафон
- Північна Корея
- Північна Македонія
- півфінал
- пігулки
- підвищення
- підвода
- підводні чрвни
- підгайці
- підготовка
- підготовка до опалювального сезону
- підготовка_до_зими
- піддубці
- підземелля
- підземні сміттєбаки
- підлітки
- підліток
- ПІдманове
- підозра
- підозрювані
- підпал
- підпал трава
- підпал_авто
- підпиємці
- підписання_закону
- підписи
- підпільна заправка
- підпільний_цех
- підприємництво
- підприємство
- підприємці
- підприємці_спрощенці
- підрізав
- підробка
- підробка документів
- підробка_номерів
- підроблене_авто
- підроблення_документів
- підручники
- підрядники
- підсумки
- підсумкове оцінювання
- підтоплення
- підтримка
- підшипник
- пікет
- пілот
- пільги
- пільговики
- пінгвін
- Піонтковський
- піротехніки
- пісні
- пісня
- пісок
- Пісочне
- пістолет
- пісчаний острів
- пітон
- піч
- пішов на дно
- пішохідний перехід
- пішоходи
- плавання
- плавці нагороди
- планета
- планування
- планшет
- пластика
- плата
- платежі
- платники
- платні дороги
- платня
- Плахотна
- плейбой
- Плотницький
- плр-тест
- плр-тестування
- пляжі_України
- пляжний_волейбол
- пляшева
- по-батькові
- побив
- побиття
- побиття_волинина
- побиттянаВолині
- побиттячоловіка
- побічні ефекти
- побічні_реакції
- повернення
- повістка
- повістки
- повітря
- повітряні ворота
- Повх
- погода
- погода_Луцьк
- погода. Луцьк
- погоді
- погоня
- пограбували
- пограбування
- пограбування волинь
- погроза
- погрози
- Погуляйко
- подаровані_кошти
- подарунки
- податки
- податківці
- податкова
- податкова служба
- податок
- податок на житло
- податок на розкіш
- подача_документів
- події
- події_люди
- Подоляк
- подорож
- подорожування
- подорожчання
- подружжя
- подяка
- поетеса
- пожежа
- пожежа луцьк багатоповерхівка
- пожежа Носачевичі
- пожежа у Брянську
- пожежі
- пожежнаслужба
- пожежні
- позбавлення
- позики
- позняковський
- позов
- поіція
- поїзд
- поїзди
- поїздка
- показ
- показники
- показники газу
- показники лічильників
- показовий
- Покальчук
- покарання
- Покрова
- Покровський
- покупка
- покупка авто
- покусав сусідку
- поле
- Полігас
- полігон
- поліетиленові_пакети
- полісся
- Полісянка
- політв'язень
- Політика
- політичне замовлення
- політолог
- поліцейська станція
- поліцейський
- поліцейський офіцер громади
- поліцейський_офіцер
- поліцейські
- поліцейські станції
- поліцейському
- поліція
- поліція охорони
- поліція. волинь
- Поліщук
- пологи
- пологовий
- пологовий будинок
- пологовй
- Положинський
- полонені
- полтава
- Полтавщина
- Полторак
- Полуйко
- поль_манондіз
- польоти
- Польща
- полювання
- поляк
- поляки
- поляков
- помер
- помер_військовий
- померла
- помилка
- поминальна
- поминальна_неділя
- помідори
- Понагайбо
- Пономарьом
- Попелюха
- попередження
- Попович
- поповнення
- поповнення_книг
- порад
- порада
- поради
- поради_фінансиста
- поразка
- поранені
- поранення
- пориви вітру
- порно
- порноактриса
- порнографія
- породілля
- Порошенко
- порошенко. звернення
- порошки
- порт Зебрюгге
- Порт Сіті
- портісіт
- Портников
- Портніков
- Портнов
- портсіті
- Португалія
- порушення
- порушення справи
- порушення_законодавства
- порушник
- порушники
- поршень
- порядність
- порятунок
- посада
- посадовець
- посадовці
- посвідення
- посвідчення
- посвідчення_водія
- посвята
- посилки
- Посівнич
- послаблення
- послуга
- послуги
- посол
- поспішайко
- Посполітак
- поставки
- поставки зброї
- постаждалі
- постачальник
- Постпред Кислиця
- постпред ООН
- постраждали
- постраждалі
- постріли
- потебні
- потепління
- потепліня
- потерпілі
- потіг
- ПОТОП
- потопельник
- потопельники
- потравили собак
- потреба
- потураєв
- потяг
- потяги
- поховання
- похолодання
- похорон
- похорони
- поцілунок
- почеснезвання
- почесний громадянин
- почесний_громадянин
- пошматоване_тіло
- пошта
- пошуки
- ППО
- права
- права водія
- права споживачів
- Правда
- правець
- правила
- правила розрахунку
- правила_дорожнього_руху
- правила_прийому
- право
- право вето
- правоохорнці
- правоохоронці
- правопорушення
- правопорушник
- правопорушники
- правопорушниця
- православ'я
- прага
- праляк
- прапор
- прапорщик
- працевлаштування
- працівники_ЗМІ
- праця
- предаставник. Верховна Рада
- предмети
- представникпрезидента
- предстоятель Російської православної церкви Кирил
- презентаці
- презентація
- презентація_книги
- презентація. Дмитро Лазуткін
- презентаціякниги
- презери
- Президент
- президент Вірменії
- президент франції
- президента
- президентські вибори
- прекурсори
- прем'єра
- премії
- премія
- премія КМУ
- премія_Лесі_Українки
- преса
- престольний празник
- прибирання
- ПриваБанк
- приват24
- ПриватБанк
- приватбанко
- приватизація
- приватизація_гуртожитки
- привітання
- привласнення
- Придністров'я
- Придністров’я
- Приднітров’я
- придорожній хрес
- приєднання
- призначення
- призов
- призовники
- призупинення
- приїзд
- приймальне відділення
- прийом
- прикарпаття
- прикмети
- прикордодння
- прикордонний_пес
- прикордонник
- прикордонники
- прикордонникик
- прикордоння
- прикоронники
- прилуцьк
- прилуцьке
- принц Гаррі
- принц Чарлз
- принц_марокко
- принцеса
- принцеса+принцеса
- Прип'ять
- припинили роботу
- припинити війну
- припис
- Припутні
- присяжні
- прихована мобілізація
- Приходько
- причина
- причина_смерті
- причини
- Пришляк
- прізвище
- про
- проблема
- провалля
- Провідна_неділя
- провокації
- прогноз
- прогноз_на_зиму
- прогноз_погоди
- прогнози
- програма
- програми
- програми держпідтримки
- програмуання
- програмування
- прогрес
- прогульники
- продаж
- продаж алкоголю
- продаж квартир
- Продаж_землі
- продажземлі
- продукти
- продукти_харчування
- продуктихарчування
- продюсер
- проект
- проєкт
- прожитковий_мінімум
- проїд
- проїзд
- проїзний
- прокопенко
- прокордоння
- прокуратура
- прокурор
- Пролісок
- промзона луцьк
- промисловість
- промінь
- промова
- пропаганда
- пропагандист
- пропагандистка
- прописка
- пропуск
- проректор
- прорив
- прослушка
- проспект волі
- проституція
- Протасевич
- протеїн
- протест
- протести
- Противник
- протипоказання
- протирання_дзеркала
- протитанкові міни
- протитанкові ракети
- протитанкові системи
- протоієрей
- протоієрей Андрій Пінчук
- протокол
- професії
- професійне свято
- професійне_свято
- професор
- профілактика
- профспілкова_бібліотека
- профтехосвіта
- профтехучилища
- прохання
- процес евакуації
- Процюк
- проща
- прощання
- прощена неділя
- Прус
- пряма_лінія
- прямий
- псевдоволонтери
- психлікарня
- птах
- птахофабрика
- пташник
- пту
- публікації
- Пугачова
- Пульмо
- ПУМ
- пункт
- пункт_пропуску
- пункт_проску
- пункти обігріву
- Пустовіт
- пустомити
- Путивль
- путівка
- Путін
- путні
- Путовіт
- пушкін
- ПЦУ
- пяний
- пясецький
- Пятерня
- Рабинович
- рабінович
- Рабіновіч
- рабство
- рада міністрів
- рада_європи
- радари
- Радбез ООН
- радзивілли
- радіаційний_фон
- радіація
- радіо
- радіодиктант
- радіонукліди
- радник
- радниця
- радовичі
- РАЕС
- разумков
- Разумков. ЗМІ
- район
- райони
- райони_Волині
- райрада
- рак
- рак у дітей
- рак шийки матки
- ракета
- ракети
- ракети "Калібр"
- ракетний удару
- ракетні системи з лазерним наведенням
- ракетні удари по ЛЬвову
- Раміс Юнус
- рана
- ранкове зведення
- рапорти на звільнення
- расизм
- ратне
- Ратнівський_розсадник
- ратнівщина
- Рахівщина
- рахунок
- РАЦС
- Рачков
- рашисти
- рда
- реабілітаційний центр
- реабілітація
- реадмісія
- реанімація
- реанімобіль
- ребрендинг
- Ребров
- Рева
- Ревенко
- Ревізор
- ревнощі
- революція
- революція_Гідності
- регіони
- реєстр
- реєстр колаборантів
- реєстрація автомобілів
- реєстрація кандидатів
- реєстрація шлюбу
- режим тиші
- режим_тиші
- режимер
- режисер
- резерв
- резервісти
- резиденція
- Резнік
- результати
- рейдерство
- рейковий_автобус
- рейковийавтобус
- рейкові партизани
- рейс
- рейтинг
- рейтинг_шкіл
- рейтинги
- реклама
- рекомендації
- реконструкція
- рекорд
- рекорд україни
- рекреаційні_пункти
- ректор
- Ректор_СНУ
- ректорСНУ
- релігія
- ремонт
- ремонт доріг
- ремонт доріг Луцьк
- ремонт_вулиць
- ремонт_доріг
- ремонт_дороги
- рентген
- РЕП
- репресії
- реставрація
- ресторан
- ретро_ФМ
- референдум
- реформа
- реформи
- реформування
- рецесія
- Решко
- рештки
- риба
- рибак
- рибаки
- рибалка
- рибалки
- рибальство
- риболовля
- риболовний патруль
- рибоохоронний патруль
- рибпатруль
- Рибчинський
- Рим
- ринки
- ринковий_курс
- ринок
- ринок землі
- ринок_землі
- ринок_праці
- ринокземлі
- Ришкевич
- рівень пожежної небезпеки
- Рівне
- Рівненська
- Рівненська_народна_республіка
- Рівненщина
- рівнодення
- різанина
- різдво
- Різдво у Луцьку
- різниця
- Рінат Ахметов
- Річард _Вайц
- Річард Мур
- річка
- річка Сейм
- річки
- річковий порт
- річний контракт
- річниця
- рішення
- РЛС
- РНБО
- РНБО України
- Роберто Де Дзербі
- робот
- робота
- роботи
- роботодавець
- роботодавці
- робоча поїздка
- робочі_місця
- Рованці
- родимки
- родина
- родини_загиблих
- родичі
- Рожище
- рожищенська громада
- Рожко
- Рожкова
- розарій
- розбещення
- розбещення дітей
- розбій
- розбійний_напад
- розваги
- розвиток
- розвиток подій
- розвідка
- роздільні смітники
- Розенблат
- Розенко
- розіграш
- розклад
- розклад руху
- розклад_руху
- розкол
- розкопки
- розлучення
- розмитнення
- розмитнення_авто
- розмітка
- розмова
- розмови
- розпуск
- розрахунки
- розслідування
- розслідувти воєнні злочини
- розстріл мирних жителів у Бучі
- розстріли
- розшук
- розшукали
- рок-версія
- Рокаш
- рокині
- ролик
- ролики
- роман
- Роман Кізима
- роман ковальчук
- Романенко
- Романчук
- Романюк
- роми
- роналду
- Росаті
- російська агресія
- російська імперія
- російська мова
- російська нафта
- російська_агресія
- російський літак
- російський нафтовий танкер
- російські активи
- російські банки
- російські війська
- Російські військові
- російські муфтії
- російські окупанти
- російські олігархи
- російські хакери
- російські_сайти
- Росія
- росія1
- росіяни
- росіянин
- рослини
- Россія
- ростб
- Ростислав Новосад
- ротація
- роттердам
- роумінг
- Рсія
- ртуть
- Рубіжне
- рублі
- рубль
- Руденко
- Рудий ліс
- Рудишин
- рукавиці
- рукопаш
- румунія
- Рустам Хамраєв
- руфер
- рух транспорту
- рух_потягів
- ручні гранати
- рушниця
- РФ
- рфеорми
- Рябікін
- Рябчук
- рядянські_мультфільми
- рятівник
- рятувальни_Волині
- рятувальник
- рятувальники
- Саакашвілі
- Сава
- Савицька
- Савіцкі
- савченко
- савчук
- Саган
- саганюк
- садівництво
- Садівські Дуби
- Садовий
- садочки
- садочок
- Сазонов
- Саїд Ісмагілов
- сайти
- сакура
- сало
- Салуха
- сальмонела
- сальмонельоз
- Салют
- Сам_вдома
- самбо
- саміт G7
- самміт
- самогон
- самогубство
- самоізоляція
- самооборона
- самооборона волині
- самопочуття
- санаторне_лікування
- санкції
- санкції на двох доньок президента РФ
- санкції рнбо
- санта
- сап
- сапалаївка
- сапери
- Сапожніков
- Сарапін
- саркасян
- Саркісян
- Сармат
- САУ "Піон"
- Сашко Лірник
- Сащук
- Сбербанк
- СБУ
- сварка
- свинина
- свиня
- свідки
- свідки_єгови
- свідомі
- світ
- світлана_бондаренко
- світло
- світло Луцьк
- світло_Луцьк
- світлофор
- Світовий банк
- Світоліна
- світоч
- Світязь
- свята
- Святаш
- святиня
- святкові дні
- святкування
- свято
- свято фермера
- свято_морозива
- Святого_Михаїла
- священик
- священики
- священник
- священники
- седлище
- сезон тиші
- Сеїтаблаєв
- секретар
- секретар РНБО
- секс
- сектор газа
- секунь
- село
- селфі
- семенченко
- Семерак
- семінар
- Сенат_США
- сенаторка
- Сенкевичівка
- Сенцов
- Сеньйоріада
- сепаратизм
- Сербія
- сервіс букбоксів
- сервісний_центр_МВС
- сервісні_центри
- сергій грибков
- Сергій Кравченко
- сергій притула
- Сергій Скулинець
- Сергій Сулима
- сергій шараєвський
- сергій_білан
- сергій_макаров
- сердечники
- середньовіччя
- серіал
- серце
- серцево-судинні захворювання
- серьога
- сесі
- сесія
- Сеул
- Сешнс
- Сєвєродонецьк
- Сєргєйцев
- сигарети
- Сидорук
- Сидорчук
- силовики
- символічна_збірна
- симптоми
- симптоми хвороб
- симфонічний оркестр
- син
- Синєгубов
- синоктик
- синоптик
- синоптики
- синя папка
- синя_папка
- сир
- сирієць
- сирія
- сирники
- Сироїд
- сирота
- Сиротинська
- Ситник
- Сі
- СІвак
- Сіверський напрямок
- СІЗО
- сік
- сільгосппродукція
- сільрада
- сімейна_медицина
- сімейний дебошир
- сімена_медицина
- Сініцин
- Сірія
- Сірники
- сіті-кард
- сітікард
- сіянці
- скажений кіт
- сказ
- скай
- скальп
- скандал
- скарб
- Скарвінко
- скарга
- скарлатина
- Скаршевський
- сквер
- скендербеу
- скіфська доба
- скіфське_золото
- склад
- складання кубика
- складання повноважень
- скликання
- скло
- скорочення
- скотч
- Скоцик
- скриннік
- Скрипін
- Скрипка
- Скрябін
- Скулинець
- скульптура
- скульптури
- скутер
- слабошпицький
- Слапчук
- слга_народу
- слідство
- Слободян
- Слов`янський базар
- словаччина
- словенія
- Слуга народу
- Слуга_народу
- служба автомобільних доріг
- службовий_пес
- слуховий апарат
- сльозогінний газ
- Смаль
- смартфон
- смартфони
- смертельн гра
- смертельна аварія
- смертельна дтп
- смертельна_аварія
- смертельна_дтп
- смертна_кара
- смертність
- смерть
- смерть дитини
- смерть_в_готелі
- смерть_від_коня
- смерть_жінки
- смерть_на_виробництві
- смерть_у_готелі
- смерть_чоловіка
- смерть. рівненщина
- смертьт
- Смерч
- Сміла
- Смірнов
- смітник
- сміттєвий полігон
- сміттєзвалище
- сміттєпереробний_завод
- сміття
- Смолигів
- Смолій
- Смолярчук
- сморід
- смс
- снайпер
- снаряди
- сніг
- снігова_скульптура
- сніговий замет
- снігопад
- СНІД
- снііг
- СНУ
- собака
- собаки
- Соборності
- сокира
- сокіл
- солдат
- солдати
- Солідарність
- соловйов
- солома
- Соломатін
- Сольський
- сом
- Сомалі
- сон
- сонце
- сонячна_електростанція
- сонячна_система
- сонячний удар
- Сопілка
- сопілкарі
- Сорокопуд
- Сорочан
- Сорочук
- сосни
- соцвиплати
- соціальна_реклама
- соціальне таксі
- соціологія
- соцмережа
- соцмережі
- соцпідтримка
- соцреклама
- соцрозвиток
- соцролик
- спалахи
- спалив авто
- Спартак
- спартакіада
- СПАС
- спека
- спектакль
- спецвипуск
- Спеціальний борт президента РФ
- спеціальний_автомобіль
- спеціальності
- спецслужби РФ
- спирт
- спиртзавод
- список заморожених російських активів
- список_47
- співак
- співачка
- співачки
- співпраця
- спікер-зона
- Спілка_воїнів_АТО
- спінери
- сплата
- сповіщення
- спогади
- Сполучені Штати
- Спорт
- Спорт_для_всіх
- спорт-лото
- спортивна хода
- спортивна школа
- спортивний туризм
- спортивні змагання
- спорткомплекс
- спортмайданчик
- спортсмен
- спортсмени
- справа_Мартиненка
- спростування
- срібло
- срібне весілля
- стабільний запас продуктів харчування
- ставок
- стадіон
- стаж
- стамбул
- стан_доріг
- стандоріг
- Станко
- станчак
- Стара Вижівка
- стара_вижівка
- старе місто
- СТарий Луцьк
- старий_Луцьк
- старий_ринок
- старість
- старовижівщина
- Старовойтове
- староста
- старости
- Стасюк
- статистика
- статитика
- статус
- стаюра
- СТБ
- створення кінопрем'єри
- Стевіч
- Стекляр
- стелла
- стендаЛь
- степан кривенький
- степан_кислюк
- Степанов
- Степанцов
- Степанюк
- стерненко
- стерненко. сутички
- стерня
- стефанович
- Стець
- стипендія
- Стир
- Стиран
- стінгери
- Стобихівка
- Столтенбегр
- столтенберг
- стоматолог
- стоматологія
- стопрак
- сторіччя
- СТорожова_застава
- Стохід
- страва
- страви
- страйк
- страсний_хід
- стратегічне планування
- страти
- страус
- страхування
- стрес
- стрибки
- Стриженова
- стрілянина
- стрітбол
- строковики
- строковики. волинь
- стронгмен
- струм
- струмівка
- Струцюк
- стугна
- студенти
- студенти СНУ
- студенти-українці
- студентка
- студентки
- Ступка
- Стус
- Стуса
- стягнення
- Су
- Су-34
- субвенція
- Сублімація любові
- субмарини
- субпроект
- субсидії
- субсидія
- суверенний дефолт
- суд
- судді
- суддя
- судна
- судно
- судова реформа
- суецький канал
- суїцид
- суми
- сумо
- Сумська
- суперечка
- супермаркет
- Супрун
- супутник
- Суркіс
- Сурков
- сурогат
- сутенер
- сутенерка
- сутенерство
- сутичка
- сутички
- суховантаж
- сучка Конні
- Сушко
- схід
- схуднення
- США
- СШІ
- Сьтарий Чорторийськ
- сюжет
- Т-72
- Табаков
- табір
- табір Вікторія
- табір_Сонячний
- таблетки
- табло
- таймер
- таксист
- тала_вода
- талага
- Тамара Андрейчук
- тамтам
- танець
- танзанія
- танзанція
- танк
- танки
- танки радянського виробництва
- танкісти
- танковий наступ
- танці
- танці з зірками
- танці_з_зірками
- тарас тополя
- тарас_шевченко
- Тарасюк
- тариф
- тарифи
- тарифи на світло і газ
- тарса
- Тартак
- татари
- тату
- тбілісі
- тварини
- тваринництво
- Твердохліб
- твіттер
- ТВК
- твори
- театр
- театральний
- текст
- телебачення
- телеканал. наш
- телеканали
- телепроект
- телерадіомарафон
- телефон_довіри
- телефони на спині
- телефонні інтервю
- Теліпський
- температура
- тенденр
- теніс
- тенісистка
- теплі_кредити
- тепло
- тепловий удар
- теплові_мережі
- теплотраса
- теракт
- Терешківці
- терещенко
- територіальна цілісність України
- Терлецький
- термаліка
- термін
- термінал
- термобарична зброя
- Тернопільщина
- тероборона
- терцентр
- тести
- тести на Covid-19
- тестування
- Тетяна Власова
- техас
- техніка
- технічний_університет
- техогляд
- техпрацівниця
- Тиводар
- Тимошенко
- Тимощук
- тимчасовийректор
- Тимчук
- тиран
- Тирастоль
- тиск
- титул
- тихановська
- Тищук
- тікток
- тіктокери
- тіла
- тіла загиблих
- Тіллерсон
- тіло
- Тіньков
- тітушки
- ткаля
- Ткач
- ткач-остапчук
- Ткачук
- ТНМК
- товариство_червоного_хреста
- токаєв
- токамак
- Токаренко
- толока
- томограф
- Томсен
- тонування
- ТОП
- ТОП-100
- тополиний_пух
- тор
- торгівля
- торгівля_людьми
- торнадо
- Торчин
- тотальна війна
- травень
- травма
- травми
- травмовані
- травневі свята
- травневі_свята
- трагедія
- традиції
- трактор
- тракторист
- трамвай
- Трамп
- транквілізатор
- трансжири
- трансплантація
- транспорт
- транспортЛуцька
- транш
- траса
- Трасс
- ТРЕК
- тренер
- тренінг
- тренування
- Трердохліб
- третій_вік
- третя хвиля мобілізації
- третя_стать
- тривалість життя
- тризуб
- Трикуш
- Трійця
- трк україна
- тролейбус
- тролейбуси
- тролейбуси Кременчук
- тролейбусна лінія
- тролейбусники
- тростянець
- Тростянки
- троща
- труни
- труп
- Трутовського
- трьохлінійка
- Трюдо
- туалет
- тубдиспансер
- ТУБЕРКУЛЬОЗ
- туман
- тур
- Туреччина
- Туреччині
- туреччинп
- туризм
- турист
- туристи
- туристична агенція
- туристичний форум
- туристичний_фестиваль
- турійськ
- турійський район
- турійщина
- турнір
- Турчинов
- тхеквондо
- тюльпани
- тюрма
- тютюн
- тютюнопаління
- УАПЦ
- убивство
- ув'язнення
- увага
- УГКЦ
- угон
- угорщина
- Угринів-Долгобичув
- удар
- ужгород
- УЗД
- указ
- укзалізниця
- Уколов
- Укр-Петроль
- укравтодор
- україна
- Україна Македонія безвізовий режим
- Україна ядерна зброя
- Україна_погода
- україна.
- українець
- україни
- українізація
- українка
- українки
- українский трейлей
- українська
- українська мова
- українська_мова
- українське громадянство
- українське_весілля
- український
- Український фільм
- українськийсолдат
- українські біженці
- українські військові
- Українські десантники
- українські села
- українські_стрільці
- українці
- украпошта
- Укргорілка
- Укрексімбанк
- Укрзалізниця
- Укроборонпрому
- УКРОП
- укрпошта
- укрспирт
- Укртрансбезпека
- укртрансгаз
- укус
- укус_змії
- уламки байрактарів
- Ульріке Груска
- ультрас
- Уляна Супрун відставка міністра охорони здоров'я
- Уляна_Бокій
- уляники
- умови
- умовне
- університет
- університети
- Універсіада_2017
- УПА
- УПЛ
- уповільненя
- уподобання
- управління праці
- управління_освіти
- УПЦ
- УПЦ КП
- УПЦ МП
- УПЦКП
- ураган
- Урал
- Ургебадзе
- урожай
- урожай зернових
- урок
- уроки
- урочистості
- уряд
- Усик
- устилгу
- Устилуг
- Устилуг_Луцьк
- УТМР
- утопленик
- утоплення
- учасник ато
- учасники
- учасники АТО
- учні
- учнівські квитки
- фавор
- фазани
- факти
- фальсифікації
- фальсфікат
- фальшиві_гроші
- фальшиві_купюри
- фальшивігроші
- фальшивомонетник
- фальшивомонетники
- фальшифомонетник
- фанати
- фанатка
- фантоми
- фармацевти
- фасад
- фацевич
- ФБР
- федерація
- Федецький
- федишин
- Федотов
- Федчишин
- феєрверки
- фейк
- фейсбук
- фельдшери
- фемен
- Фенікс
- фенольний завод
- фермер
- фермери
- Фесенко
- фестиваль
- фестиваль фізкультури
- Фестиваль_пива_і_м'яса
- фестиваль_повітряних_куль
- фетр
- фізики
- фіксація руху
- філарет
- філармонія
- Філіп
- Філіпчук
- Філозоф
- Філонюк
- фільм
- фільм_10_й_блокпост
- фільми
- Філюк
- фінал
- фінансові порушення
- фінансові санкції ЄС
- фінансування
- фінляндія
- Фіолет
- фірсов
- ФІФА
- ФК "Волинь"
- фк_волинь
- флайза
- флеш-моб
- флешмоб
- флешмоб луцьк
- флікери
- флойд
- Флорбол
- Фокус
- фонд держмайна
- фонтан
- фонтани
- фоп
- форма
- форум
- форум видавців
- форум_видавців
- фото
- фотовиставка
- фотозона
- фотосесія
- фракція
- фракція_Ляшка
- франківщина
- франтовська
- франциск
- Франція
- французькі жандарми
- Френк Макрей
- Фріланд
- фсб
- ФСБ Севастополя
- фуд фест
- фудфест
- фундук
- функція
- фура
- футбоілст
- футбол
- футбол. Волинь
- футболіст
- футболісти
- ффтаж
- ФФУ
- Х-фактор
- хабар
- хакери
- хаос
- Хара
- Харитонюк
- харків
- Харківська ОДА
- харківські угоди
- Харківщина
- Харція
- Харчишин
- харчування
- Хасевич
- Хатинь
- Хацкевич
- хвора_вчителька
- хворий_волинянин
- хвороба
- хвороби
- хвороби_ніг
- хдоров'я
- Хелм
- хеловін
- хельм
- херсон
- херсонщина
- хибний_виклик
- хілінський
- хімікус
- хімічна зброя
- хімічна зюроя
- хімічне ураження
- хімія
- хірургічне відділення
- хліб ціни
- хлопчик
- хмара диму
- Хмарук
- хмельницький
- хмельниччина
- хода
- ходьба
- хокей
- холейко
- холера
- холі
- Холмська_ікона
- холодильник
- Холодницький
- Холонів
- Холостяк
- хор
- хореографія
- хорлупи
- хотимчук
- хотячів
- хоцунь
- храм
- хресний хід
- хрещення русі
- хрещення_Русі
- Христина Соловій
- християни
- хрінники
- хробаки
- хроніки
- Хрущов
- Хряськ
- художник
- художники
- художниця
- художня_гімнастика
- хук
- хуліган
- хулігани
- хуліганство
- Хулусі Акар
- Хурсенко
- хуртовина
- Цаплюк
- цар
- цвинтар
- цвк
- цвях
- цензура
- Центр протидії дезінформації
- центральний парк
- Центральний_парк
- центральний_ринок
- цеперів
- церква
- цетральний парк
- цех
- цигарки
- Цизла
- циклон
- цирк
- цитати
- ціна
- ціна-_на_газ
- ціни
- ціни на землю
- цінні речі
- ЦНАП
- црл
- цска
- цукор
- цукровий
- цукровий діабет
- цукровий_діабет
- Цукровий_завод
- Цуманська_пуща
- Цумань
- Цьось
- Цюриць
- чадний газ
- ЧАЕС
- Чайковський
- Чаклуни
- Чапюк
- чаруків
- чат-бот
- чаус
- чебелюк
- чевона_книга
- челеднж
- челендж
- чемпіонат
- чемпіонат Європи
- чемпіонат_Європи
- чемпіонат_світу
- чемпіонат_України
- чемпіонка Європи
- ченці
- черазе
- червень
- червона зона
- Червона_книга
- Червоний
- червоний хрест
- Червоний_Хрест
- Червоноград
- черги
- черги на кордоні
- чергування
- черепи
- черкаси
- Черних
- Чернівці
- чернігівщина
- Черновецький
- черняков
- Черче
- Чехія
- Чечня
- Чиж
- чиновниця
- чирков
- чисельність
- чистий_четвер
- чистка
- чистка у ФСБ
- чистота
- Чіхоцкі
- члени
- члени НАТО
- чоловік
- Чоп
- Чорний
- Чорний Ліс
- чорний_список
- Чорниці
- чорниця
- Чорнобиль
- Чорнобильська зона відчуження
- чорнобильці
- Чорнобіль
- чорнобривці
- Чорновіл
- Чорногорія
- Чорноморський флот
- Чорнуха
- ЧС-2018
- Чубаров
- Чубач
- чугуєв
- чудотворець
- Чужа_молитва
- чума свиней
- Чумак
- Шабанов
- шавлк
- ШАГ
- шальке
- Шамбір
- Шаповалов
- шарій
- Шаров
- шахи
- шахіст
- шахраї
- шахрай
- шахрайка
- шахрайство
- шахрайство.Волинь
- шахта
- Шахтар
- шахтарі
- шахти
- Шацьк
- Шацьке_товариство_мисливців_та_рибалок
- Шацький_парк
- Шацькі озера
- Швейцарія
- Швеція
- швидка
- швидка допомога
- Швидкий
- Шевченко
- Шевчук
- Шелеп
- Шем’єн
- шеремет
- Шеремета
- шериф
- шериф громади
- шерифи
- шершень
- Шехтман
- Шиба
- Шиманська
- шина
- Шишкін
- Шишко
- шкарпетки
- шкідник
- шкідники
- шкільні автобуси
- шкільні табори
- шкільному лісництві
- шкіряк
- школа
- школа_влогінгу
- школа_екскурсовода
- школа_журналістики
- школа_плавання
- школа_публіцистики
- школа-інтернат
- школа№27
- школи
- школяр
- школярі
- школярка
- шлагбаум
- шлюб
- шлюб за добу
- шмигаль
- Шмулевич
- Шойгу
- Шольц
- Шон Пенн
- Шосте чуття
- шоу
- шпак
- Шпига
- шпилясті кобзарі луцьк
- шрифт
- шрифт брайля
- шрі-ланка
- штаб
- штаб оборони
- штам
- штами
- штанга
- Штанмаєр
- Штанько
- Штепсель і Тарапунька
- шторм
- штормове пепередження
- штормове попердження
- штормове попередження
- штормове_попередження
- штраф
- штрафи
- штурм
- штурмове_попередження
- штучні квіти
- шульська
- шульц
- шум
- Шумельда
- Шуст
- шуфрич
- шухевич
- щасливе
- щастя
- щедрик
- щедрівки
- щеплення
- ювенальна превенція
- ювентус
- ювілей
- ювілейний термінал
- Юзевський
- юлія_вусенко
- Юлія_Тимошенко
- юнак
- юнаки
- юнацька команда
- юний динамівець
- юний_волинянин
- ЮніорБанк
- юніори. приватбанк
- юнона
- Юпітер
- юридичний департамент
- юринець
- юрій вітренко
- юрій погуляйко
- юрій розанов
- Юрій Романюк
- Юрій_Кресак
- юрченко
- Ющенко
- ющук
- Я бачив Бучу
- яблука
- Яворський
- ягідництво
- ягоди
- ягодин
- Ягодинська митниця
- ядерна війна
- ядерна зброя
- ядерна_війна
- ядерна_зброя
- ядерні сили
- як працює "орсар"
- Якимчук
- яковенко
- Яковлев
- ялинка
- ялта
- ями
- Яна Беломоїна
- Янголята
- Яндекс
- Янукович
- Яодин
- Японія
- японські лікарі
- Яременко
- Ярина Каторож
- ярмарка
- ярмарок
- Ярмоленко
- Ярмольський
- Ярмолюк
- яровиця
- Яручик
- яхта
- яценко
- Яценюк
- Усі
- Муждабаєв Айдер
- Братущак Олексій
- Гриценко Анатолій
- Матвійчук Анатолій
- Білецький Андрій
- Піонтковський Андрій
- МОШКУН Андрій
- Андрій ПЕТРУШКО
- Іллєнко Андрій
- Миселюк Андрей
- Коваль Анна
- Аваков Арсен
- ШИБА Богдан
- Буткевич Богдан
- Буткевич Богдан
- Береза Борислав
- Філатов Борис
- Андрощук Дарина
- Богуш Денис
- Коротєєва Діана
- Тузов Дмитро
- Гитюк Олена
- Кузьменко Євген
- Корбан Геннадій
- Луценко Ігор
- КАРПЮК Ілона
- Інна Кошулинська
- Баран Ірина
- Зенц-Власюк Ірина
- Сварник Іван
- Павлова Катерина
- Добровольський Кирило
- Клімчук Анастасія
- Еггерт Костянтин
- Олексюк Костянтин
- Соляник Олена
- Бондарук Леся
- Сидорук Максим
- Тетюрко Марія
- Топтун Марія
- Хоміць Марта
- Бродський Михайло
- Подоляк Михайло
- Жернаков Михайло
- Томенко Микола
- РОМАНЮК Ніна
- Забужко Оксана
- Швець Оксана
- Литвин Оксана
- Точинський Олег
- Чеславський Олег
- Тягнибок Олег
- Вишняков Олег
- Єльцов Олег
- Добко Олексій
- Гарань Олексій
- Мозгова Олена
- Шкрум Альона
- Бацман Олеся
- Олеся Нижник
- Кушнарь Олександр
- Богомолець Ольга
- Ведрін Олів'є
- Сохар Орест
- Дроздов Остап
- Дроздов Остап
- Розенко Павло
- Казарін Павло
- pravda
- Волинська Правда
- Марчук Валентин
- Колюхов Роман
- Шрайк Роман
- Колюхов Роман
- Чапюк Ростислав
- Мельник Руслана
- Глузман Семен
- Середюк Олександр
- Дацюк Сергій
- Кічий Сергій
- Іванов Сергій
- Фурса Сергій
- Струцюк Йосип
- Лесюк Святослав
- Самарук Таня
- Футрук Тарас
- Власова Тетяна
- Власова Тетяна
- Боярин Тетяна
- Самарук Тетяна
- Камінський Володимир
- Мельник Валентина
- Нагорний Василь
- Чумак Віктор
- ВЕРБИЧ Віктор
- Пясецький Віталій
- Портников Віталій
- Фесенко Володимир
- Рожко Володимир
- Пасевич Яна
- Рибчинський Євген
- Бистрицький Євген
- Червюк Юлія
- Кравчук Юлія
- Бутусов Юрій
- Юрій Онищук
- Стригун Юрій
- Злата Максимук
14.08.2020
Опублікував Злата Максимук в 14.08.2020
Категорії
У зв’язку зі здійсненням технічних робіт на теплових пунктах, у п’ятницю,14 серпня, у Луцьку на деяких вулицях не буде світла. Адреси, де відімкнуть електропостачання: з 09:00 […]
Сподобалась публікація?0
14.08.2020
Опублікував Злата Максимук в 14.08.2020
Категорії
Традиційно День молоді в Україні відзначають наприкінці червня, втім, через карантинні обмеження у Луцьку прийняли рішення перенести святкування на серпень. У світі Міжнародний день молоді відзначають […]
Сподобалась публікація?0
14.08.2020
Опублікував Злата Максимук в 14.08.2020
Категорії
Луцький Фотограф Роман Домбровський поділився вражаючими світлинами з нічної фотосесії, де зазнімкував зорепад Персеїди. Про це він написав на своїй фейсбук-сторінці. «Бачили багато гарних. Але виявилось, що […]
Сподобалась публікація?0
14.08.2020
Опублікував Злата Максимук в 14.08.2020
Категорії
В Україні запустили універсальний гаманець для сервісів компанії Facebook – Facebook Pay. Наразі через додаток можна зробити пожертвування через вбудований механізм збору грошей на Facebook. Про […]
Сподобалась публікація?0
14.08.2020
Опублікував Злата Максимук в 14.08.2020
Категорії
Реальною опозицією до влади найбільша кількість українців вважає партію “Європейська Солідарність”. Про це свідчать результати соціологічного опитування, проведеного Центром Разумкова та Центром SOCIS з 21 по […]
Сподобалась публікація?0
14.08.2020
Опублікував Злата Максимук в 14.08.2020
Категорії
Вірус – це неклітинний інфекційний агент, який може відтворюватися лише всередині живих клітин. Віруси вражають всі типи організмів. Це крихітні мікроби, які технічно є паразитами, тому […]
Сподобалась публікація?0
14.08.2020
Опублікував Злата Максимук в 14.08.2020
Категорії
У Міністерстві охорони здоров’я України пояснили, як саме можна заразитися сибіркою, а також назвали симптоми при захворюванні. Зараження відбувається в результаті проникнення збудника через пошкоджену шкіру, слизову оболонку […]
Сподобалась публікація?0
14.08.2020
Опублікував Злата Максимук в 14.08.2020
Категорії
На Волині відкрили сезон полювання і через це окремі мисливці та рибалки часто залишають сміття у лісах чи інших місцях перебування. Про це повідомляють у пресслужбі […]
Сподобалась публікація?0
14.08.2020
Опублікував Злата Максимук в 14.08.2020
Категорії
Теофімо Лопес прийняв умови бою за титул абсолютного чемпіона світу в легкій вазі проти Василя Ломаченка. Тепер очікується, що він відбудеться 17 жовтня і буде транслюватися […]
Сподобалась публікація?0
14.08.2020
Опублікував Злата Максимук в 14.08.2020
Категорії
14 серпня за новим стилем в народі святкують свято Маковея ,яке в церковному календарі називається днем семи мучеників Маковеїв. З цього дня розпочинається «Спасівка» – піст, […]
Сподобалась публікація?0